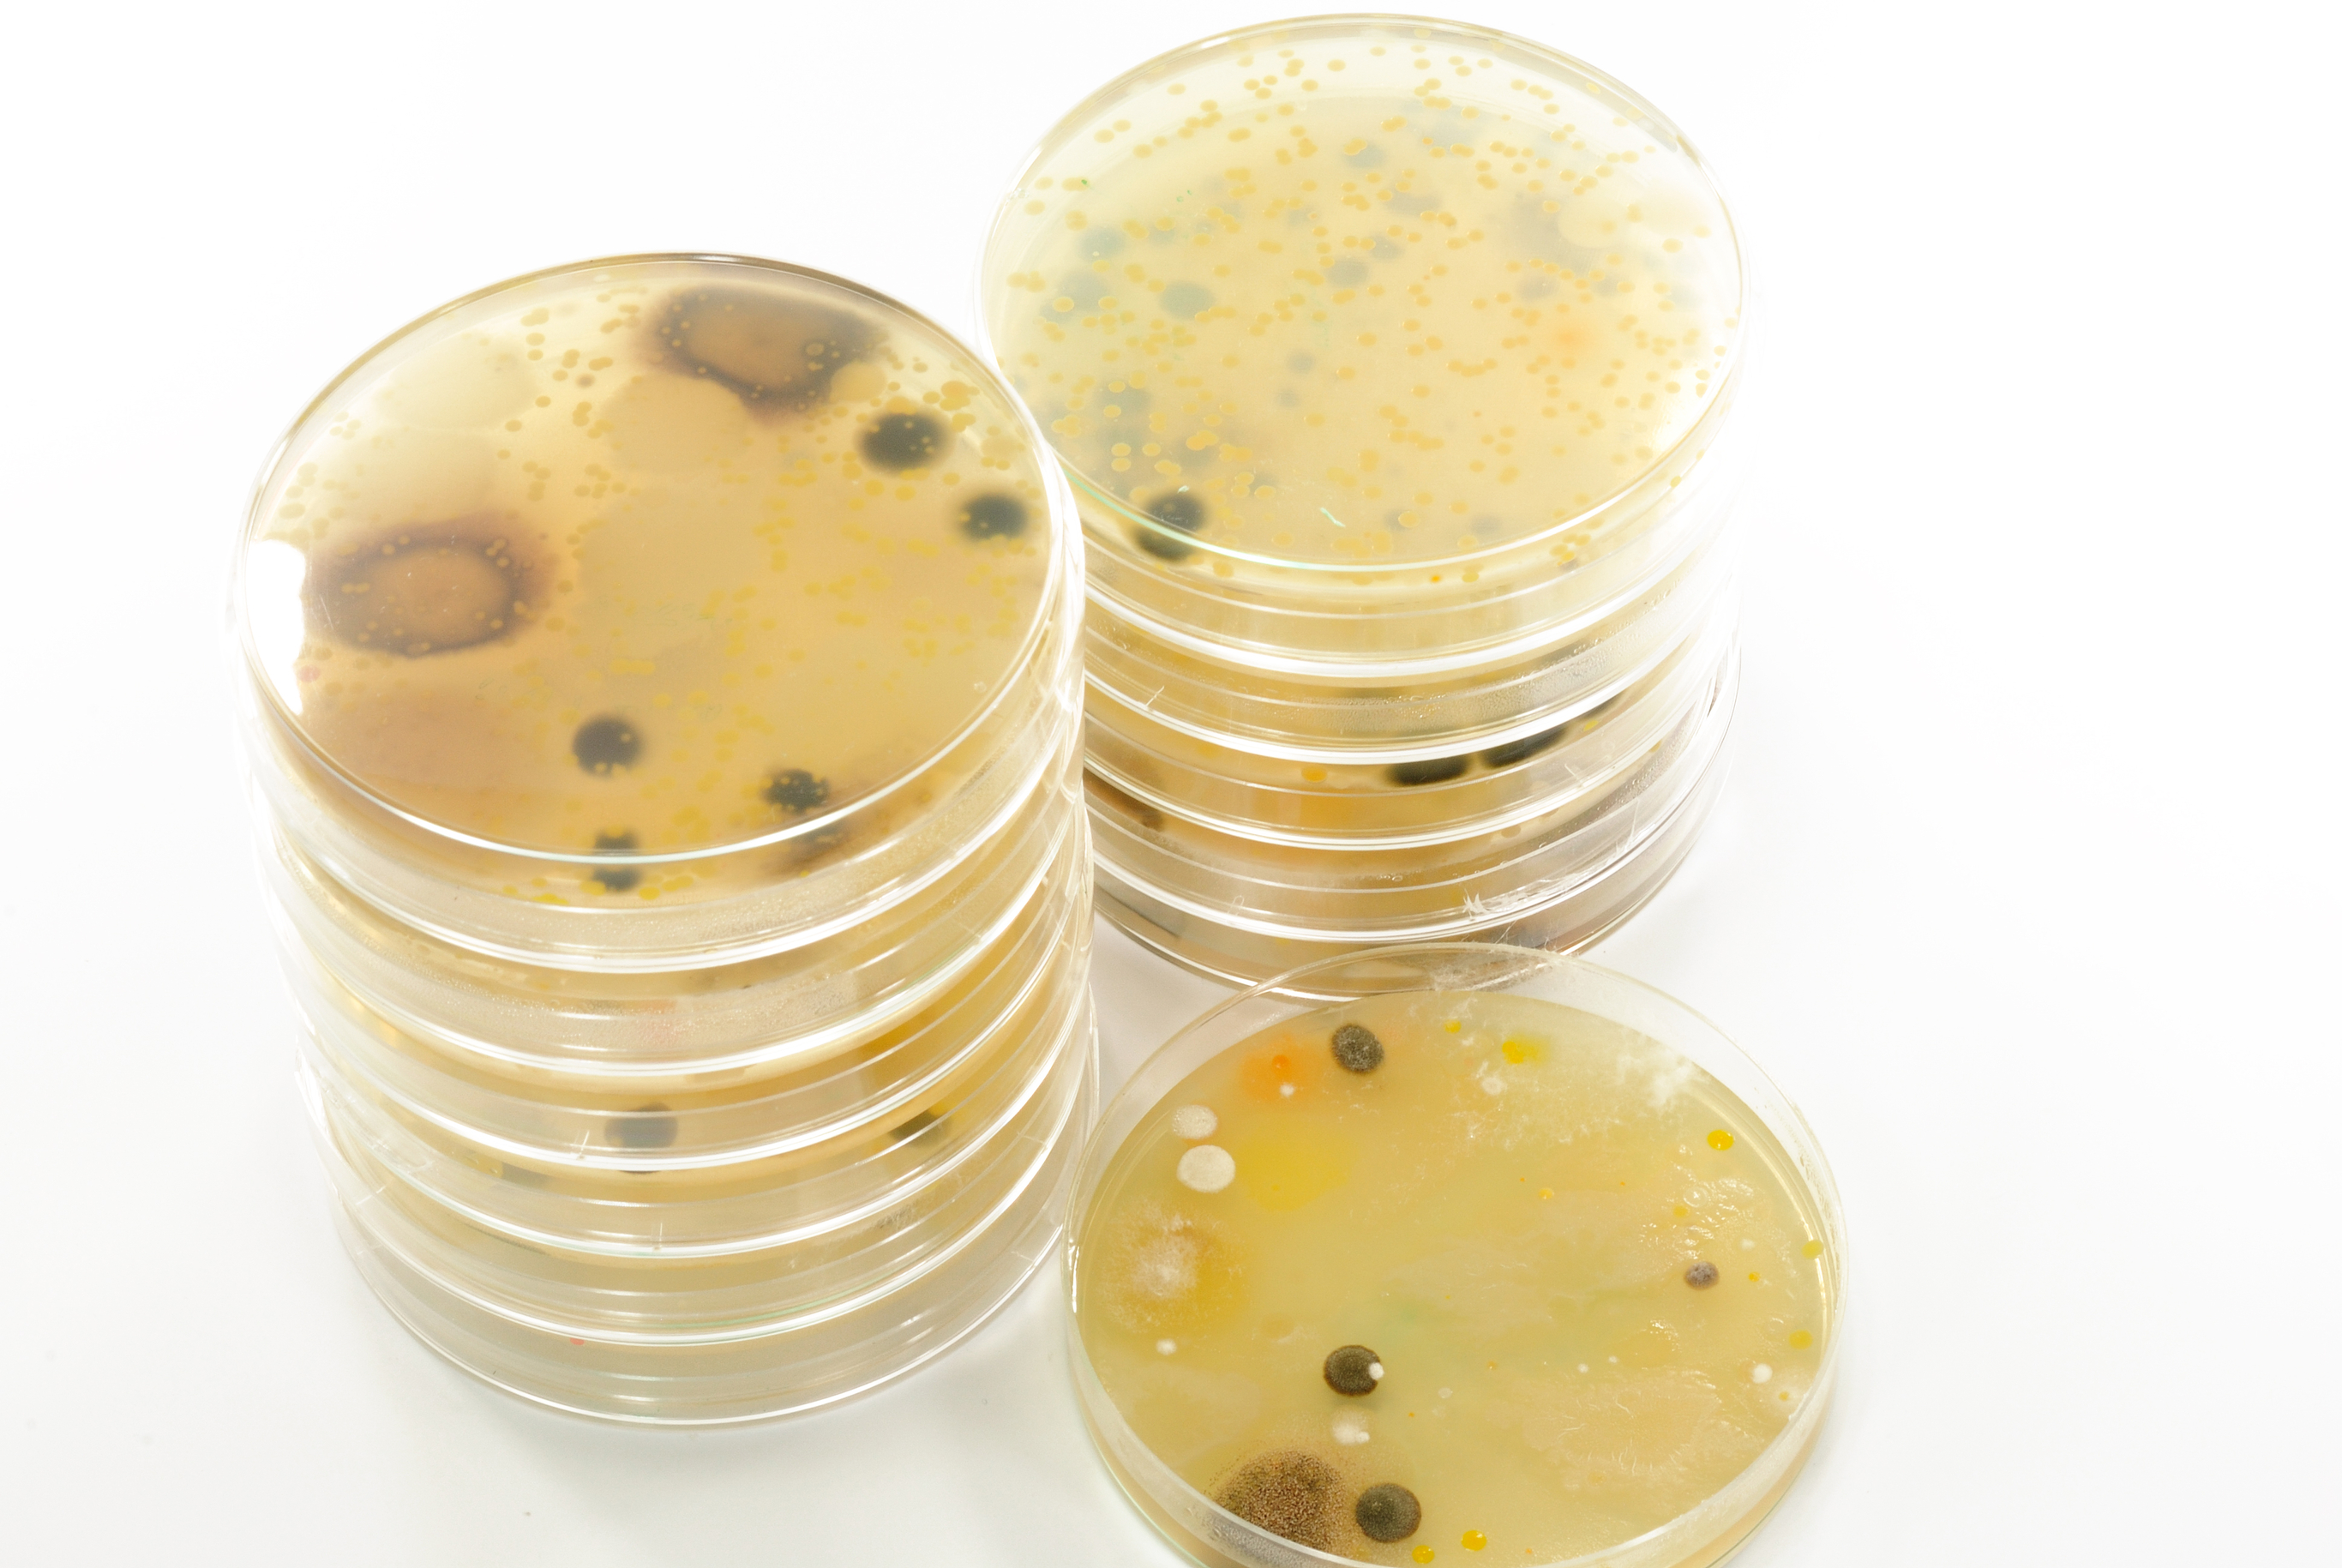

最近更新中文字幕手机版|
4四虎影库永久在线|
免费观看欧美日韩亚洲|
青青草视频在线观看免费|
JIZZZJIZZJI大|
欧美三级韩国三级日本一级|
国产精品久久久久一区二区三区共|
免费永久观看美女视频网站网址|
亚州日韩精品AV片无码中文|
国外免费精品视频在线观看|
国产精品久久久久久亚洲色欲|
国产成人无码AV麻豆|
AAA国语精品刺激对白视频|
美女丝袜一区二区三区|
欧美又大又粗又湿A片|
欧美国产一区二区不卡|
www.夜夜撸.com|
国产精品岛国久久久久久|
日韩在线观看精品|
欧美又硬又粗进去好爽A片|
久久精品一区二区三区不卡牛牛|
日本无码一区二区三区不卡毛片|
四川少妇BBB凸凸凸BBB安慰我|
日本一道综合久久?ⅴ免费|
欧美の无码国产の无码影院|
免费人做人爱视频在线观看|
99国产婷婷综合在线视频|
色综合亚洲色综合久久网张柏芝|
av天堂天堂久久久av不卡|
60老熟女多次高潮露脸视频|
亚洲一区二区久久av网站
|
19不插片免费视频|
色婷婷亚洲婷婷五月|
亚州AV无码乱码色情|
小嫩妇好紧好爽18禁视频|
国产精品视频一区二区三区|
伊人影院蕉久影院直播福利|
特级做A爰片毛片A片免费|
精品人妻一区二区A片|
边摸边吃奶做爽A片视频|
把舌头伸进去添我的批真舒服视频|
日本VA在线视频播放|
亚洲欧视在线观看|
成人国产精品影院|
人妻被黑人猛烈进入A片|
色婷婷亚洲婷婷7月|
青草精品国产福利在线视频|
早上躁晚上躁天天躁8090|
99国产精品视频免费观看一公开|
亚洲无码淫荡人妻对白|
久草在线草a免费线看|
欲香欲色天天天综合和网
|
国产乱妇无码一区二区三区黑寡妇
|
女神漫画页面免费漫画在哪里看|
国产又粗又猛又爽又黄A片小说|
日韩一卡2卡三卡4卡 免费网|
99九九精品国产高清自在线
|
国产色情A片国语露对白|
精品中文字幕乱码一二|
又粗又大又黄的少妇毛片|
国产真实伦在线播放|
中文字幕日韩精品有码视频|
又黑又粗又大的欧美A片|
乱理片 最新乱理片2018|
亚洲AV国产精品无码精|
5av国产精品爽爽ⅴa在线观看|
青柠社区视频在线高清完整|
成人欧美一区二区三区A片|
一本大道一卡二卡免费|
国产av无码专区亚洲av蜜芽 |
人妻饥渴偷公乱中文字幕|
亚洲人妻av无码|
caoporn超碰发布页|
两人做人爱视频在线观看|
亚洲精品久久久WWW|
亚洲不卡在线观看|
变态Sm天堂无码专区|
国产爆乳成人AV在线播放|
www亚洲无码A片|
XXX波多野结衣苍井空|
巨胸美女狂喷奶水www网麻豆|
无码人妻一区二区三区A片|
人妻被粗大猛进猛出国产|
欧美成人观看免费全部完小说|
苍井空一级婬片A片AⅤ网站
|
永久免费看A片无码播放器不卡|
国产精品_卡2卡三卡4卡|
日本少妇啪啪后式动态图片|
骚虎成人免费99XX|
蜜桃AV色偷偷AV老熟女|
日产区一线二线三线A7778|
九九久久精品国产免费看小说|
国产做A爰片久久毛片A片软件|
成人Av一本不卡二卡|
欧美性猛交XXXX乱大交3|
凸偷窥wc女厕所学生在洗澡|
少妇搡BBBB搡BBB搡忠贞|
亚洲欧美婷婷五月色综合麻豆
|
国精品产露脸偷拍视频|
在线永久免费观看黄网站|
国产人妻人伦AV又粗又大|
色情久久XXX免费播放器|
无码人妻久久一区二区三区免费人妻|
波多野吉衣一二三区乱码|
91精品国产免费久久久久久青草|
97超碰人人澡人人爱学生|
●苍井そら无码流出videos
|
亚州码欧州码一二三区|
内射爽无广熟女亚洲|
91人妻岛国视频免费看|
四川女人毛多水多A片|
内射中出无码护士在线|
金发欧美一区在线观看|
内射老妇女BBWXOCLOCK|
a级男女性高爱潮高清试看|
国产精品亚洲天堂网不卡|
成人视频在线视频|
亚洲色无码A片一区二区潘甜甜|
2023海角最新回家路|
男人猛躁进女人毛片A片|
www一区二区三区中文字幕|
国产极品JK白丝喷白浆在线观看
|
一本道不卡中中文无码|
国产www片在线观看高清视频|
国产乱码日产精品BD|
婷婷综合五月丁香97视频资源在线|
91精品在线观看第一页|
国产精品自产拍在线观看首页|
99r视频国产在线观看免费|
成人精品一区日本无码网站|
天堂VA蜜桃一区二区三区|
69SEX久久精品国产麻豆|
麻豆 天美 果冻 星空国产|
国产又黄又猛又粗又爽的A片动漫
国产精品热久久高潮AV袁孑怡
|
最近中文字幕MV在线视频2019|
国精产品999一区二区三区有限|
a级男女性高爱潮高清试看|
高潮精品视频国产|
精品国产乱码一区二区三|
日本色情初来交国产|
丰满少妇内射一区|
香蕉AV福利精品导航|
韩国乱码卡一卡二新区网站|
欧美日韩精品无码免费看A片|
日韩色情无码免费A片|
国产真实乱人偷精品人妻69|
少妇被躁爽到高潮无码人狍大战|
最近最好最新2019中文字幕免费|
91无码精品人妻一区二区|
www亚洲国产成人|
99成人在线视频|
亚洲精品久久无码AV片俺去也|
李采潭和黑人做在线看|
撸啊撸激情五月色|
亚洲乱码AV久久久久久久|
91精品在线观看第一页|
又大又粗的欧美激情A片
|
成人做爰WWW网站视频
|
日日摸天天碰中文字幕|
成年美女黄网站色大免费视频|
蜜色欲多人AV久久无码|
成全久久免费高清大全AV|
91人人妻人人澡人人爽国产网址|
久久久久国产精品www|
日本三级香港三级三级人!妇久|
国产精品久线观看视频|
老少欢另类日本xxx|
拔擦拔擦8X永久华人免费播放器|
992TV精品视频TV在线观看 |
刮伦人妇A片1级|
风间由美人妻无码AV|
fc2人成视频在线观看|
国产偷人爽久久久久久老妇APP
|
欧美成人久久一二三区A片|
国产精品野外AV久久久|
国产无遮挡裸体免费视频A片软件|
中文字幕人妻无码精品一区二区|
巨爆中文字幕区乳爆中|
精品熟女少妇AV久久免费A片|
强开乳罩摸双乳吃奶视频|
www.youjizz.com中国|
亚洲卡一卡二卡三乱码公司|
国产亚洲精品A片久久久|
69SEX久久精品国产麻豆|
亚洲国产精品无码久久久久久久久|
成年人短视频在线观看网站|
黑人狂躁中国人的A片刘玥|
日本一本道无码a在线|
97se色在在线视频|
日韩午夜资源在线|
女人喷射视频在线播放你了|
成人无码免费A片免费看软件|
亚洲AV色情成人www|
国产人妻精品久久久久久|
校花夹震蛋上课爽死H女女|
91 国语精品自产拍在线观看|
免费午夜扒丝袜www在线看|
高潮娇喘抽搐A片无码黄|
h黄免费观看在线视频|
欧美精品一卡2卡3卡4卡乱码|
狠狠躁夜夜躁人人爽A片|
91精品国产91久久综合瑜伽|
亚洲人妻av无码|
国产精品99久久久久久久女警|
特级毛片绝黄A片免费播冫|
2024中文字幕99精品视频|
真人做爰欧美AAAAA|
四平青年之喋血曼谷免费观看完整|
99久久免费看少妇高潮A片|
狠狠躁日日躁夜夜躁A片小说按摩|
日本三级香港三级三级人!妇久|
91av视频在线观看|
强奸日本大奶子片一区二区|
免费看美女禁处爆涌视频|
新婚偷拍盗摄视频真实|
小辣椒AV成人无码国产|
2020年最新国产精品正在播放|
日韩一二区色情高清清视频|
h成年动漫在线看网站|
日韩精品一区二区三区中文|
99人中文字幕亞洲區 |
国产XXXXXX农村野外|
日本免费视频观看MV|
亚洲精品爆乳一区二区
|
亚洲乱码中文字幕久久孕妇|
久草在视频免费福利|
97精品久久久大香线蕉|
2019中文字乱码字幕100页|
岛国美女全棵写真视频在线观看|
丁香综合缴情六月婷婷 |
欧美性潮喷XXXXX无码|
成人美女黄网站18禁免费|
第四色播日韩AV第一页|
内射在线CHINESE|
最新国产一二三区无码|
龙欲h粗喘强占公妇H|
国产精品正在播放|
国产午夜精品一区二区三区四区|
日产无码AV在线观看|
成人性生交A片免费网|
18禁外国精品久久久久久|
粉嫩大学生无套内射无码卡视频
|
午夜精品成人一区二区视频|
看中国日B大片大片|
国产精品1区2区3区|
最新欧美精品一区二区视频
|
91精品国产观看免费观看|
岛国色情A片无码视频免费看|
亚洲精品无码成人A片在|
男女生爽爽爽视频免费观看|
天海翼第一次与黑人|
狠狠躁日日躁夜夜躁A片55动漫|
蜜臀AV色欲A片无人一区|
日本又色又爽又黄的A片视频免费
亚洲区色情区激情区小说纯熟调抖
|
亚洲无码精品推荐|
97国产自在线拍|
丰满多毛大隂户XXXHD|
真实国产精品视频国产网|
国产色情乱码久久久久一区二区|
成人无码精品一区二区|
日本xxxxxxx69xx|
AA片在线观看视频在线播放|
最近中文字幕完整版2019免费|
欧美精品一级一区|
99久久精品无码专区免费|
中国的黄片1级片看一下视频|
91精品久久久久久久久中文字
|
三级成人AV电影在线观看|
精品爽爽久久久久久蜜臀|
女人色国产a精品|
色情成人免费视频激情在线观看|
强硬进入岳A片69|
日韩一卡2卡3卡4卡乱码网站导航|
96在线热播视频|
久久6热在线视频精品8|
国产成人se在线播放|
白又丰满大屁股BBBBB|
色情AB又爽又紧无码网站|
18以上黄色内射国产影院|
国产乱辈通伦在线观看|
国产一级性爱视频|
日韩欧美一区二区三区在线|
无码国产精品一区二区色情男同|
边吃胸边膜下床震免费版视频
|
成人污污视频在线观看|
国产卡一卡二无线乱码|
国产免费不卡旳无码a片|
高清一区二区三区免费视频|
国产精品视频永久免费播放
|
丰满少妇呻吟高潮经历|
av男人的天堂免费在线观看|
鲁丝一区鲁丝二区鲁丝AⅤ|
青青草视频在线观看免费|
国产精品久久..4399|
www.久久精品视频|
国产亚洲一区呦系列|
又硬又粗进去好爽A片春色视频|
亚洲成a人v欧美综合天堂下载
|
99热国产这里只有精品9九|
欧美又大又粗又硬又色A片|
国产又色又爽又刺激在线观看|
99热在线精品一区二区三区|
宝贝好紧好爽再搔一点试視頻|
一本道不卡中中文无码|
闷骚的小少妇全程露脸|
高清国产摸出水在线视频|
97人伦影院A片在线观看|
两女互慰AV高潮喷水在线观看|
浪潮AV色综合久久天堂|
2021精品高清卡1卡2卡3麻豆|
乱码一区二区三区竹菊|
成年美女黄网站色大免费全看|
啊灬啊灬啊灬快灬深用力A片男男|
亚洲精品久久无码AV片俺去也|
新67194成在线入口|
国产XXXXXX农村野外|
91麻豆精品国产91久久久久久久久|
亚洲视频在线观看网站|
亚洲卡通另类欧美|
成人啪啪高潮不断观看|
99久久久无码国产AAA精品|
少妇伦子伦情品无吗|
又色又爽又高潮免费视频观看|
扒开老师粉嫩的泬10P|
yourporn久久国产精品|
国产在线一区二区三区|
亚洲精品久久久久久AV|
国产成人精品一区二三区在线观看|
成人免费视频在线观看|
野花视频免费观看2019|
HEYZO中文字幕无码|
a篇片在线观看快播|
国产影视无码久久|
国产成人无码一区AV在线观看|
香蕉视频免费版在线高清全集|
激情欲成人AV在线观看AV性|
一个人免费观看的WWW在线国语
|
成全动漫视频在线观看免费高清版下载|
美女被抽插舔B到哭内射视频|
三级无码AV在线观看网址|
熟女人妻精品一区二区三|
精品国产福利一区二区在线|
免费观看a毛片一区二区不卡|
天天影视亚洲综合网|
国产成人精品日本亚洲11|
果冻传媒人妻国产精品苏畅|
国产一区二区无码精品小说|
扒开腿挺进肉嫩小泬喷水网站|
791国产亚洲精品视频第1页|
日本三A级做爰片啊荒野下载|
品产品久精国精产拍完整百科|
人妻无码一二三区|
日本少妇无码一区视频|
成人亚洲天堂av在线|
国产做爰高潮呻吟视频|
直接看的成人无码视频网站|
日日摸天天碰中文字幕|
91在线精品免费观看 |
99久久久久久亚洲精品|
国产二级一片内射视频播放|
国产乱码卡二卡三卡4|
精品视频在线观看|
亚洲成人在线免费观看|
国产精品亚洲综合欧美第一区|
男人天堂网2018最新地址|
成年人视频免费在线|
天天综合网在线观看视频|
女性奴跪爬伺候调教虐|
搡BBBB搡BBBB搡BBBB|
中国人泡妞www免费|
99e热在这里只有精品 |
午夜亚洲福利在线老司机|
看国产一级特黄大片在线一|
国产精品1区2区3区|
影音先锋av网站大全|
国产亚洲精品久久77777|
日韩女优一区二区三区|
一本大道一卡二卡三卡四卡在线观|
国产三级精品三级在线观看
|
日本无吗无卡v清免费网站|
小SB真紧好爽快夹断了视频|
国产精品一级黄色在线播放|
99热在线精品一区二区三区|
av在线播放成人|
国产人妻午夜在线无码|
日本韩国性高潮视频在线免费|
日本一本二本无码免费视频|
99r视频国产在线观看免费|
亚洲精品美女av在线|
国产又粗又猛又爽又黄A片小说|
被操高潮受不了视频|
国产精品A久久久久久久久|
国产成人av三区|
亚洲AV久久无码精品九九小说|
一卡二卡三卡四卡无卡免费播放在线观看
|
草草影院永久线路CCYY|
嫩bbb搡bbbb搡视频|
明星性猛交ⅩXXX乱大交|
福利姬国产精品一区在线观看|
任你干在线精品视频网2|
浮妇高潮喷白浆视频 |
韩国乱码卡一卡二卡新区网站|
亚洲精品无码成人A片在线漫画
|
精品日韩中文字幕无码专区
|
国产乱码日产精品BD|
a9av红番阁免费观看|
四虎影视成人精品|
国产色情18一20岁片A片下载|
调教超级YIN荡玩物学生H|
国产欧美精品一区二区三区APP|
最近日本MV字幕免费观看视频|
女人爽得直叫免费视频|
亚洲高清国产拍精品5g|
小明看看wwwxXX.2015|
亚洲中文无码永久免费|
狠狠躁18三区二区一区|
日韩在线卡2卡3卡4卡5卡免费|
影音先锋av在资源天堂|
国产精品一区二区 尿失禁|
精品日产卡一卡二卡麻豆|
2017中文字字幕66页|
国产偷摄中国推油按摩富婆|
日本一卡2卡三卡4卡无卡免费网站|
亲胸揉胸膜下刺激视频免费版全集|
亚洲国产精品福利在线无卡一|
2021国产最新盗摄在线播放|
少妇性BBB搡BBB爽爽爽小说|
亚洲一线二线三线品牌精华液久久久|
久久精品AV无码一区二区小说|
国产人妻人伦AV又粗又大|
国产又色又爽无遮挡免费|
久久亚洲AV成人无码电影A片|
四川揉BBB搡BBB|
欧美做A视频一区|
5av国产精品爽爽ⅴa在线观看|
中文字幕亚洲男人的天堂网络|
国产午精品午夜福利757视频播放
麻豆果冻传媒在线观看
|
免费黄色福利网站网址|
国精品产露脸偷拍视频|
国产人妻精品午夜福利免费不卡|
老牛无码人妻精品1国产|
精品亚洲麻豆1区2区3区|
国产色婷婷亚洲99麻豆|
公天天吃我奶躁我A片|
欧洲一卡2卡3卡4卡免费高清|
免费观看成人毛片A片2008|
国产成人AV大片大片在线|
男人到天堂a线牛叉在线|
无套内谢大学生A片|
国产白丝精品爽爽久久蜜臀|
多毛熟女HDVido多毛的简介|
少妇人妻真实偷人精品视频|
真实国产精品视频国产网|
一边喂奶一边挨CAO|
鲁丝片一区二区三区四川人|
乱码中字芒果视频一二三多人|
日韩色情图片小说AV一区|
性插图动态图无遮挡|
和少妇人妻邻居做爰无码|
在线偷着国产精选视频|
疯狂揉吮少妇嫩草99AV小说|
成人午夜福利入口|
亚洲老司机成人精品影院|
www.色情.com|
国产精品久久久久久久久图地区|
特级黄色一级片免费观看视频|
夫妻互换精品三级国产 |
亚洲AV久久婷婷蜜臀无码不卡|
国产露脸精品国产探花|
刮伦人妇A片1级|
97超级碰碰碰免费公开在线观看
|
国产亚洲精品久久久久久国|
国产白丝美腿娇喘高潮的视频|
外国多人做人爱的视频|
亚洲精品毛A片久久久爽|
亚洲中文字幕久久精品无码喷水|
日本A级做爰午夜免费视频|
女人18毛片a级毛片|
a9av红番阁免费观看|
99精产国品一二三产品香蕉|
日韩精品欧美视频|
www.337h.com|
毛一卡二卡三卡免费看|
日本高色高清视频免费|
丁香五月 激情 婷婷|
四虎8848a成人亚洲五品|
色7久久另类图片免费版|
苍井空无码换线观看|
少妇熟女视频一区二区三区|
91蜜桃在线观看|
成年美女黄网站18禁动态图片|
国产偷国产偷亚州清高APP|
午夜DY888国产精品影院|
国产做爰高潮呻吟视频|
色片段高清在线观看|
无码无遮挡成人A片|
欧美丰满少妇久久无码精品|
一区二区久久久久草草|
亚洲AV无码乱码精品国产白浆|
成人免费视频在线观看|
国产又黄又刺激的免费A片小说|
欧美日韩免费在线|
伊人大蕉久75影院在线播放|
一本久道久久综合狠狠爱一密臀精|
久久久久无码精品国产sm果冻|
亚洲精品乱码8久久久久久日本|
日韩丰满少妇无吗视频激情内射|
超碰在线97国产久中文|
日韩精品一区二区三区中文|
AV无码AV天天AV天天爽|
亚洲A片成人无码久久精品色欲|
中文字幕一区二区在线2021|
色情A片成人网站免费看|
国产无套内射又大又猛又粗又爽|
亚洲精品国产嫩草在线观看东京热|
亚洲精品久久国产片麻豆|
福利日木AV无码专区亚洲AV毛片|
国产又粗又硬又大爽黄老大爷视频|
99精品众筹模特私拍|
欧美日韩一级特大黄片|
www.狠狠撸.com|
国产精品无码免费专区午夜小说|
四虎成人午夜影视亚州精品|
99国产成人精品无码青春|
日韩一卡2卡3卡4卡乱码|
成年女人色费视频免费|
国精品人妻无码一区二区三区性色|
自拍h视频一区二区|
香蕉国产精视频在线观看|
国产女教师一级爽A片|
成全视频在线观看BD|
麻花豆传媒剧国产MV天美|
日韩亚洲福利网站|
苍井空A级在线观看网站|
国产亚洲一区二区在线观看|
果冻传媒人妻国产精品苏畅|
影音先锋大型av资源|
激情做a全过程片A|
国产成人无码一区AV在线观看|
免费啪视频观看视频|
午夜宅宅伦电影网中文字幕|
爱啪网亚洲第一福利网站|
精品一区二区三区四区免费AV|
久久免费看少妇高潮A片手机版|
精品少妇人妻AV无码专区偷人|
色久优优欧美色久优优|
婷婷亚洲综合小说图片|
欧美又粗又大又黄A片|
福利一区二区在线视频网|
亚洲国产主播精品二区|
色就色综合偷拍区欧美|
香蕉视频三级强奸|
又大又粗又爽免费视频A片|
亚洲精品乱码一区二区三区|
天美传媒小甜豆完整视频在线观看|
中文字幕亚洲欧美日韩2019|
欧美又粗又大又黄A片|
亚洲中国老头老太性hd|
mdapptv麻豆入口|
精品人妻无码一区二区三区手机版
|
久久夜色精品国产飘飘|
亚洲精品国偷拍电影自产在线
|
粉嫩的女同事24p|
222aaa.com男人天堂|
国产极品JK白丝喷白浆在线观看|
乳液全集电影在线观看|
亚洲精品无码成人A片在线漫画|
熟婦人妻系列AV無碼一區二區|
日本一级一片免费视频|
亚洲色熟偷拍视频在线|
中文字幕无码A片一区在线观看|
国内精品一区无码中文在线|
久久久久亚洲视频
|
一个人免费视频在线观看高清直播|
91免费一区二区久久|
免费费很色视频大片|
91久久夜色精品国产网站|
麻豆一区二区三区蜜桃免费|
欧美高清免费刺激视频网站|
最近中文字幕手机大全|
未满十八岁成年禁止观看亚洲天堂
|
av专区在线播放|
成人免费AA片在线观看|
2014av天堂影音先锋|
一个人免费视频在线观看高清直播|
美女视频黄a视频全免费网站色窝|
色情A片成人网站免费看|
艳妇荡岳丰满交换做爰电影|
男妓跪趴把舌头伸进我的嘴巴
|
亚洲AV无码久久蜜桃杨思敏|
粗大的内捧猛烈进出A片黄|
中文字幕黄色av首页网站|
国产性猛交普通话对白|
国产免费无码成人A片在线观看|
亚洲无线看天堂av|
乱亲女洗澡69XX|
十八禁的黄污污免费网站|
无码精品一区二区三区潘金莲|
久久亚洲AV成人无码电影A片|
亚洲欧洲无码AV在线观看你懂的|
国产伦精品一区二区免费|
色欲久久精品AV无码|
日韩一区二区三区视频在线观看|
国产老熟女伦老熟女熟妇图片|
69无码人妻互换A片|
91蜜汁在线一区二区三区|
免费A片全黄少妇内谢|
国产无码在线视频VIP|
亚洲国产欧美日本视频|
国产精品人妻无码久久久郑州|
岳的大肥屁熟妇五十路99|
欧美日产成人高清视频|
狼群视频在线观看免费完整版|
无码又爽又刺激视频A片涩涩|
国产精品自在自线亚洲|
荡妇肉欲乱色欲av浪潮|
亚洲一区在线电影|
白丝jk网站国产免费|
久久久无码精品一区二区三区|
久久频这里精品99香蕉久网址|
亚洲精品无码成人A片在|
99久久国产综合精麻豆|
免费国产香蕉尹人在线|
亚洲中文AⅤ中文字幕艳妇|
麻花豆传媒剧国产MV天美|
国产成人va免费视频 |
免费看成人A片无码视频网站|
免费观看a毛片一区二区不卡|
亚洲高清91在线|
91人妻互换一区二区三区|
影视AV久久久噜噜噜噜噜三级|
摸添揉捏胸还添下面视频|
国产狂喷水潮免费网站www|
性一乱一交一A片.看A片|
国产一级黄色现场视频在线观看|
成人黄色小视频在线观看|
国产色情性黄片免费网址|
亚洲aⅤ无码专区国产乱码不卡|
jiucao在线观看精品|
日韩一区二区三区四区|
久久久久成亚洲综合精品|
最近的中文字幕在线看视频|
波多野吉不卡中文AV无码AV|
国产又粗又猛又爽又黄的视频黑鬼|
精品一区二区三区在线成人|
www.日本视频在线观看|
99在线精品视频在线观看3|
最新麻豆av在线播放|
校花夹震蛋上课爽死H女女|
国产精品欧美日韩人妻|
强开少妇嫩苞又嫩又紧九色|
国产97精品无码A片在线看密
|
丰满人爽人妻A片二区|
影音先锋亚洲AV少妇熟女|
中日韩高清无专码区2021|
性色A码一区二区三区天美传媒|
亚洲人妻av无码|
新婚人妻不戴套国产精品|
最近中文字幕完整版2019免费|
亚洲自偷自偷在线制服|
黄片长版看嘛 直播片|
好大灬好硬灬好爽灬无码日本|
91中文日韩欧美 |
日韩人妻无码精品A片免费不卡|
91人妻互换一区二区三区|
WWW.色噜噜.COM|
www.亚洲天堂|
国产人妻无码鲁丝片久久麻豆|
中文字幕黄色av首页网站|
最近的中文字幕在线看视频|
99久久就热视频精品草|
高清毛片AAAAAAAAA片|
亚洲AV久久爆乳一区二区|
扣扣传媒MV在线播放|
亚洲精品久久久久久AV|
成人精品视频99在线观看免费|
国产精品久久久久无码人妻精品|
xart欧美一区在线播放|
在线观看美女洗澡青青草|
阴部内射好爽性视频成人|
午夜精品视频一区二区在线观看|
国产精品A成V人在线播放|
欧美成人AAA毛片|
91av视频免费在线观看|
国产综合av一区|
亚洲午夜久久久久久国产精品
|
日本一级特黄大片AAAAA级|
国产av丝袜熟女丰满一区二区 |
亚洲国产精品无码久久久久久久久|
国产东北三老头伦一肥婆|
伊人久久大香线蕉AV一区二区|
国产AV无码专区亚洲AV久久|
最近的中文字幕在线看2019|
日本阿v手机不卡在线观看视频|
大肉大捧一进一出视频出来呀视频社区在线|
在办公室里揉弄小雪好爽|
亚洲一卡2卡3卡4卡乱码网站|
幺女幺女在线看国产毛片|
91av视频免费在线观看|
亚洲精品无码一二区A片|
女人被添全过程A片久久AV|
日小骚B少妇真舒服|
成人亚洲色欲色一欲WWW|
国产SUV精品201|
成人午夜AV亚洲精品无码网站|
熟岳大屁股疯狂迎合|
国产欧美亚洲欧美另类在线|
91亚洲最新精品|
国产高潮A片羞羞视频涩涩|
日韩一卡2卡三卡4卡 免费网|
亚洲AV成人影视在线观看|
变态Sm天堂无码专区|
99久久久无码国产精品不卡|
黄色视频免费久久久久|
国产宾馆偷爱视频在线观看|
狼群视频在线观看免费完整版|
欧美高清免费刺激视频网站|
女人与牲囗牲恔视频免费|
丁香六月婷婷七月激情|
精品亚洲国产成人AV制服丝袜
|
捏胸亲嘴床震娇喘视频在线播放|
一女三男做2爱A片免|
亚洲成av人片在线播放无码|
天天综合网在线观看视频|
av免费在线观看最新网址|
色欲狠狠躁天天躁无码中文字幕
|
国产无遮挡又黄又爽又色|
成人Av鲁丝片一区二区鲁大师|
亚洲成av人片在线播放无码|
97在线精品国自产拍|
精品三级毛片在线观看|
国产精品大陆偷拍视频|
亚洲色婷婷久久精品AV蜜桃久久
|
最近2019免费中文字幕视频三
|
色片段高清在线观看|
欧美激情一区二区三区四区|
姝姝的白丝又湿又紧|
国产精品亚洲第一区在线暖暖韩国|
拔擦拔擦8X永久华人免费播放器|
点击进入av毛片在线|
日韩欧美国产一区啊|
国产天堂AV在线色|
夫目前犯人妻av中文字幕|
99xxxx.com|
日本三区四区免费高清不卡|
国产超碰女人任你爽|
A片扒开双腿猛进入免费观|
国产精品美女在线看片|
成人国产日本亚洲精品|
亚洲国产精品成人a|
亚洲精品久久久久一区二区三区
|
亚洲午夜精品A片久久WWW慈禧|
亚洲精品夜夜做人人爱|
99久久就热视频精品草|
精品一区二区三区在线成人|
成人 亚洲一区二区|
黄网站免费永久在线观看下载
|
国产午夜亚洲精品区|
亚洲精品gv天堂无码男同娇喘|
成人女人a毛片在线看|
大战熟女丰满人妻AV|
惠民福利无码少妇精品一区二区免费动态|
亚洲日韩大佬色蜜桃91|
白丝班长被弄得娇喘不停在线观看
|
肉乳床欢无码A片120秒|
边做边爱完整版免费视频在线播放|
5av国产精品爽爽ⅴa在线观看|
AA片在线观看视频在线播放|
天天爽亚洲中文字幕|
老少欢另类日本xxx|
中无码人妻丰满熟妇啪啪18禁|
亚洲国产日韩a线视频|
精品日产一卡2卡三卡4卡乱码
|
午马视频影院1区2区3区4区|
97人妻久久久精品系列A片|
亚洲无码免费高清视频|
影音先锋av男人资源|
女人被添全过程A片免费视频|
亚洲老司机成人精品影院|
国内精品一卡二卡三卡公司|
久久精品香蕉绿巨人登场|
国产亚洲精品久久久久久老妇小说|
一道本无吗d d在线播放|
国产亚洲一区二区在线观看|
999亚洲精品无码久久久久|
国产亚洲精品久久久久久白晶晶|
日本老妇一级特黄aa大片|
亚洲欧美高清无码专区|
男女一级A片免费播放
|
不卡高清中文字幕在线播放|
91妻人人澡人人爽人人精品|
久激情内射婷内射蜜桃
|
国产做爰又粗又大又大|
无尺码精品产品视频|
小嫩妇好紧好爽18禁视频|
亚洲视频在线观看网站|
校花夹震蛋上课爽死H女女|
乱码无人区一卡二卡观|
午夜播放器在线观看|
HEYZO中文字幕无码|
三A级做爰片奶大叫不停图片
|
凸偷窥wc女厕所学生在洗澡
|
青青青国产精品一区二区|
无人区乱码一线二线忘忧草|
国产浓毛大泬熟妇视频|
久久免费看少妇高潮A片手机版|
凸偷窥wc女厕所学生在洗澡
|
亚洲性线免费观看视频成熟|
国产成人黄色视频|
97SE亚洲精品一区|
91九色熟女欧美日韩欧美|
蜜桃av色偷偷av老熟女|
亚洲精品深夜AV无码一区二区|
国产精品色情国产三级在线观
|
欧美V国产V亚洲V日韩九九|
国产又黄又刺激的免费A片小说
|
色一情一乱一乱一区99AV|
精品乱码一二三四区别|
91人妻互换一区二区三区|
全部AV极品盛宴|
特级毛片AAAAAA|
苍井空一级A片免费播放|
成人免费一区二区三区|
狠狠躁日日躁夜夜躁A片|
国产亚洲一区二区三区啪|
一级av中文字幕在线观看|
国产福利一区二区三区在线视频|
精品无人区卡一卡二卡三|
狠狠cao日日穞夜夜穞视频图|
又粗又大又黄的少妇毛片|
在线高清国语成人网站|
亚洲AV色情成人www|
试看免看一级a一片
|
美女脱内衣禁黄止18以下免费|
国产亚洲日本精品无码电影|
国产精品久久人妻无码蜜|
无套内谢少妇毛片A片小说作者|
精品无人无码乱码毛片国产小说|
18禁美女黄网站色大片免费看|
国产黄片按摩视频|
亚洲人成77777A片张津瑜|
无码人妻丰满熟妇惹区|
国产亚洲va在线电影|
97人妻超在线观看免费|
成人精品一区二区不卡视频|
日日摸夜夜添夜夜添A片看见
|
人人爽久久久噜噜噜丁香|
国产熟妇的荡欲午夜视频|
久久精品久久久久|
WWW色视频片内射|
惠民福利无码少妇精品一区二区免费动态
|
3344com.成年站|
成人女人爽到高潮的A片羞羞动漫|
国产特黄又粗又硬A片|
广东BBW搡BBBB搡|
久久草视频这里只精品|
国产精品久久久久久久久久两年半|
激情内射人妻1区2区3区|
熟婦人妻系列AV無碼一區二區|
欧美の无码国产の无码影院|
国产成人无码一区AV在线观看|
欲香欲色天天天综合和网|
亚洲精品无码成人A片在|
欧美成人精品动漫在线专区|
蜜色欲多人AV久久无码|
一级特黄特色的免费大片视频|
国产传媒果冻天美MD|
国产XXXXXX农村野外|
凌晨三点看片www巨乳|
91成人啪国产啪永久地址|
免费三级片中文字幕无码|
日本一道人妻无码一区视频|
深夜动态福利GIF动态图900期|
又大又硬又粗做大爽A片无册|
91天堂精品在线观看|
国产亚洲精品一级āv三级无码毛片
|
大尺度一对一视频聊天APP 2019|
国产精品人妻久久AI换脸
|
对白精彩的国产3p视频|
天天鲁一区摸一摸爽一爽
|
扣扣传媒MV在线播放|
2021最新亚洲精品无码|
中文字幕日韩精品有码视频
|
2019午夜视频福利在线|
MIMISEQINGWANG|
国产精品成人观看视频免费|
91成人免费网站 |
丰满多毛大隂户XXXHD|
A片人澡C片人人妻|
亚洲成A人片在线播放器|
秋葵APP下载汅API免费麻豆色多多|
日本乱偷人妻中文字幕|
成人性生交A片免费的网站|
FREE性开放小少妇|
大屁股国产白浆一二区|
两女互慰AV高潮喷水在线观看
|
老熟女重囗味HDXX69|
亚洲成人黄色网址|
一个人看片视频www|
影888午夜理论不卡|
成人无码精品一区二区|
狠狠躁夜夜躁人人爽A片|
欧洲一卡2卡3卡4卡免费高清|
欧洲一区二区三区网站|
九色91精品国产网站|
乳液全集电影在线观看|
欧美午夜精品一区二区三区电影|
国产午夜鲁丝无码拍拍|
国产又黄又猛又粗又爽的A片小说|
国产亚洲一二三区精品免费视频观看|
一级a免费观看完整视频|
他扒开我奶罩揉吮我奶头在线视频|
又硬又粗进去爽A片免费无码安娜
中文字幕在线不卡视频蜜乳
|
国产美女高潮福利|
波多野结衣一本道在线|
69网站黄色免费观看 |
jijzzizz老师出水喷水多毛|
永久免费在线观看视频|
老师的粉嫩小又紧水又多A片视频|
色情A片成人网站免费看|
欧美两性人xxxx高清免费|
性色A码一区二区三区天美传媒|
亚洲视频在线观看一区|
久久久久无码精品国产sm果冻|
午夜dj在线观看大全|
少妇饥渴偷公乱AV在线观看涩爱|
成人性生交A片免费看网|
麻豆一区二区三区蜜桃免费|
亚洲熟妇av一区二区三区色堂
|
日本卡一卡二卡三入口|
4438成人-全国|
五月色婷婷中文开心字幕|
av在线观看网站免费|
日韩一区二区三区四区|
免费看少妇高潮A片黄|
日本人做爰大片免费观看|
歪歪爽蜜臀AV久久精品人人槡|
精品国产偷窥一区二区久久|
电影888午夜理论不卡|
国产JK白丝喷白浆一区二区|
AV久久无码AV喷水高潮|
国产精品自产拍在线观看首页|
99热夜色精品三级免费观看|
19不插片免费视频|
欧美又黄又大又爽A片|
未满十八岁成年禁止观看亚洲天堂|
成都视频高清完整版在线观看|
日产乱码一区二区三区在线|
Free HD XXXX DH 69|
老头巨大挺进莹莹的体内免费视频|
日韩色情无免费高清在线视频
|
色情亚洲AV成人小说|
抖音WWW视频在线观看|
成人无码T髙潮喷水A片动漫小说|
国产成人91国精品|
成人啪啪免费无码网站|
免免费国产AAAAA片|
欧美精品久久久久久无码人妻|
亚洲第一成人无码A片|
亚洲一区二区三区乱码在线欧洲|
51久久成人国产精品麻豆|
亚洲精品拍拍央视网出文|
91精品国产观看免费观看|
国产精品无码免费专区午夜小说|
成人无码T髙潮喷水A片动漫小说
|
在线高清国语成人网站
|
美女被抽插舔B到哭内射视频|
精品国产偷窥一区二区|
91久久香蕉青青草原娱乐 |
丁香综合缴情六月婷婷 |
97色伦午夜国产亚洲精品|
婷婷激情五月AV在线观看|
99久久精品国内|
国产免费人成xvideos视频|
青青草原精品国产亚洲AV|
麻豆视传媒短视频免费|
女人被添全过程A片免费视频|
国内精品一区二区三区视频|
最近2019中文字幕在线看|
天堂在线观看国产精品|
丰满熟妇大号BBWBBWBBW|
四个熟妇搡BBBB搡BBBB|
亚洲高清无码不卡在线视频|
日本少妇无码一区视频|
色老头永久免费视频|
丰满女邻居做爰B|
国产精品日本不卡一区二区|
永久久久免费人妻精品|
男女狂进狂出动态图GIF|
91精品国产现在观看|
国产精品久久人妻无码波多野结衣|
亚洲国产综合久久久久|
歐美在線中文字幕|
中国黄页网站大全免|
欧美h版经典手机在线看|
日韩性做爰免费A片AA片|
欧美综合在线网不卡|
91精品国产欧美一区二区|
chinese中国人自拍在线|
国产极品JK白丝喷白浆在线观看|
最近2019中文字幕免费直播|
日产幕无线码三区在线|
入室强伦轩人妻HD|
好想被狂躁A片免费久99|
欧美毛片又大又粗无码电影|
yellow视频中文字幕|
亚洲AV成人无码久久精品麻豆|
一区国产传媒国产精品
|
免费费很色视频大片|
欧美肉体视频一进一出在线|
亚洲av无码日韩av无码|
久久免费看少妇高潮A片特黄多
|
国产AV高清怡春院|
精品网址你懂的在线观看|
又硬又粗进去爽A片免费无码安娜
中文字幕在线不卡视频蜜乳
|
XXX18在线观看免费图片|
97爽a高清免费在线观看|
91人妻岛国视频免费看|
特黄AAAAA免费A片毛多水多|
欧美黑人添添高潮A片WWW|
久久久GOGO无码啪啪艺术|
久久久久99999热只有精品|
亚洲一区二区三区四区五区6区|
色欲AV亚洲AV无码精品|
日本三A级做爰片啊荒野下载|
亚洲产国偷V产偷V自拍色情|
国产无遮挡又黄又爽又舒服|
精品人妻一区二区A片|
日本又黄又爽gif动态图|
国产亚洲va在线电影|
国产精品亚洲综合久久综合亚洲鲁鲁五月天
|
曰本人做爰大片免费观看一
|
欧美高清免费刺激视频网站|
日本无码一区二区三区不卡毛片|
国产小视频免费在线观看|
熟女视频国产小伙子在线播放
|
狠狠色综合7777久夜色撩人|
人妖又长又粗又大的巴|
学生处破女A片免费观看|
日韩一二区色情高清清视频|
明星性猛交ⅩXXX乱大交|
爆乳2把你榨干哦OVA在线观看|
国产卡一卡二卡3卡4乱码|
国产精品亚洲天堂网不卡|
日本一区二区在线视频观看
|
成人好吊妞在线播放|
国产精品悠悠久久人妻精品|
黑人欧美巨大xxxxx69|
A级A片A少妇高潮|
成人国产三级在线|
惠民福利国产精品一区二区欧美视频
|
麻豆乱码1区2区新区|
变态Sm天堂无码专区|
日本又色又爽又黄的A片视频免费
亚洲区色情区激情区小说纯熟调抖
|
亚洲国产一卡2卡3卡4卡5公司|
无码人妻视频又大又粗欧美|
在线偷着国产精选视频|
国产成人AV激情在线播放|
日本人强伦姧人妻A片|
成人啪啪高潮不断观看|
爆乳滛妇一级毛片手机扳免费观看|
进去粗粗硬硬紧紧的好爽免费视频
|
av专区在线播放|
影音先锋资源av不撸|
成年美女黄网站色大免费全看|
国内精品乱码卡一卡2卡三卡新区|
69爱妃免费视频福利|
国产三级精品三级在线观看专1|
人妻少妇被粗大爽9797PW|
97超人人澡不卡|
2019午夜福利ak在线|
日本又色又爽又黄的A片视频免费|
亚洲欧美成人高清在线|
人妻被黑人猛烈进入A片|
黄se网站是多少2013|
新超碰97在线观人人澡|
国产精品久久久久久久久图地区|
豪妇荡乳1一5杨贵妃|
国产精品人妻无码久久久竹菊影视|
五月色综合网天天综合网|
午夜精品久久久久久99热软件|
51无人区码一码二码三码区别|
●苍井そら无码流出videos|
欧美囗交xx bbb视频|
色欲人妻无码AV专区|
黑寡妇巨大粗爽毛片欧美|
嫩bbb搡bbbb搡视频|
国产av1插花菊综合网|
欧美无人区码卡二卡3卡4|
蜜桃人妻一区二区三区欧美|
国产午夜精品理论片小yo奈|
日日鲁鲁鲁夜夜爽爽狠狠|
国产av无码专区亚洲草草|
成人综合久久精品色婷婷|
久久99精品国语久久久|
亚洲v欧美v日韩v国产v91|
99re热在线视频|
黑人狂躁中国人的A片刘玥|
女人被添全过程A片免费视频|
91精品免费久久久久久久久|
色情无码WWW视频无码区下载|
男人到天堂a线牛叉在线|
huangseajipian|
国产乱辈通伦在线观看|
亚洲香蕉一区二区三区|
亚洲国产一卡2卡3卡4卡5公司|
精品无码国产一区二区三区av|
老女老肥熟国产在线视频|
国产精品V无码A片在线看|
美女诱惑亚洲一区|
操人亚洲欧美精品 |
亚洲精品久久久鸭子|
肉嘟嘟WWW视频在线观看高清|
亚洲AV成人无码人在线观看堂|
国产人妻人伦AV又粗又大|
欧美丰满熟妇BBB久久久|
brazzers欧美精品|
亚洲另类欧美在线电影|
一区二区三区不卡在线观看
|
日本三A级做爰片啊荒野下载|
免费jlzzjlzz在线播放中国|
国产无遮挡又黄又爽又色|
国产高清色情在线观看APP|
欧美の无码国产の无码影院|
www.337h.com|
成人天堂婷婷青青视频在线观看|
91国产自产精品a|
日韩精品卡1卡2三卡四卡乱码|
av综合中文字幕|
亚洲欧美成人高清在线|
中文字幕丰满孑伦无码精品|
乱码一区入口一欧美
|
亚洲色无码A片中文字幕|
国产无码一二三专区|
国产男女做爰猛烈叫床小说|
无码专区文字幕无码野外|
国产精品久久久久久亚洲色欲|
99国产中文字幕|
无码又爽又刺激视频A片涩涩|
44西西人体做爰大胆视频|
亚洲欧美韩国综合色
|
91精品欧美久久久久久久|
少妇又大又粗又硬啪啪|
亚洲精品久久7777777|
中医少妇私密推油SPA露脸偷拍|
日本黄H兄妹H动漫一区二区三区|
精品人伦一区二区三区蜜桃网站|
亚洲AV久久婷婷蜜臀无码不卡|
精品一卡二卡三卡四卡网站|
把舌头伸进去添我的批真舒服视频|
少妇无码吹潮久久精品AV网站
|
4HU影库最新永久地址入口|
午夜福到在线4国产|
国产亚洲精品久久久久久久久动漫|
国产磁力链接在线播放|
97人摸人人澡人人人超一碰
|
亚洲AV成人男人的天堂网|
国产精品久久人妻无码蜜|
性少妇中国内射XXXX狠干|
国产成人精品123区免费视频|
成人午夜高清无码|
日本少妇啪啪后式动态图片|
激情欧美日韩一区二区|
国产玉足榨精视频在线观看|
粉嫩的女同事24p|
在线成本人视频动漫 www|
把舌头伸进去添我的批真舒服视频|
黄色片色狼片爽爽爽|
A片好大好紧好爽视频免费|
青青青国产精品一区二区|
免费做爰猛烈吃奶摸视频在线观看
|
国产精品悠悠久久人妻精品|
精品免费看一区二区三区A片|
国产精品_卡2卡三卡4卡|
蜜桃AV色偷偷AV老熟女|
97精品国产高清自在线看超|
女人爽到喷水的视频大全在线观看
|
四川少妇ddd凸凸凸ddd|
亚洲精品无码一二区A片|
无码欧美喷潮福利XXXX|
亚洲日韩精品AV成人波多野结衣|
国产色情A久久无码影|
在线视频免费观看爽爽爽|
韩国日本免费不卡在线丷|
日本特黄特色特爽大片|
亚洲日韩精品AV中文字幕|
一本道道中文无码无卡|
国产精品无码人妻99999|
乱熟女高潮一区二区在线|
中无码人妻丰满熟妇啪啪18禁|
一个人免费观看的WWW在线国语|
国产you女视频|
欧美特级特黄AAAAA片|
草草福利欧美中文字幕免费|
80岁老熟妇乱子伦牲交|
婷婷97狠狠成人网站|
亚洲卡二卡三无线乱码新区|
国产成人a在观看网站国产成人|
饥渴难耐的浪荡艳妇在线观看|
亚洲乱码一卡二卡四卡乱码新区|
日韩一卡2卡三卡4卡 免费网|
12一14性xxxxx国外|
老师的粉嫩小又紧水又多A片视频|
中文字幕在线不卡视频蜜乳|
粉嫩av一区二区白浆|
国产沙发午睡对白高清|
香蕉视频免费版在线高清全集|
亚州码欧州码一二三区|
51精品久久亚洲中文无码|
日本又黄又爽又色又刺激的视频|
日本高清h色视频在线观看|
日本又色又爽又黄的A片视频免费|
影音先锋av网站大全|
麻豆视传媒app官方下载|
丁香六月婷婷七月激情|
小明看看2017永久网站|
亚洲精品一区二区三区无码A片
|
黄AV国产永久免费网站|
亚洲中文字幕婷婷在线的|
最近最好最新2019中文字幕免费|
不充会员的爽爽影院|
国产人妻午夜在线无码|
亚洲AV国产精品无码A片APP|
无码无遮挡成人A片|
少妇对白半推半就高清AV|
四虎成人午夜影视亚州精品|
麻豆传煤APP免费网站网址高三
|
免费视频网站一级人爱视频|
婷婷色一区二区三区|
丁香六月婷婷七月激情|
日本VA欧美VA精品发布|
国产精品成人va在线观看网|
少妇老师寂寞高潮免费A片|
精品无码久久久久久国产|
国产免费无码又爽又刺激A片动漫
韩国青草视频19禁福利
|
欧美成人午夜精品久久久|
大胆L少妇BBBBBB流水|
丁香婷婷五月情天|
久久精品国产亚洲AV蜜臀|
中文字幕色欲AV亚洲二区|
国内精品自在自线视频|
欧美S码亚洲码精品M码|
色欲久久精品AV无码|
日本卡一卡二卡三入口|
最近2019手机中文字幕下载|
嫩模写真一区二区三区三州|
操逼视频白浆游戏亚洲骚妇|
欧美全黄a一级一区二区三区视频|
丰满熟妞区欧美黄色免费|
在线观看亚洲精品国|
91中文日韩欧美 |
一级A婬片试看28分钟|
中文字幕乱码一区AV久久|
久久久无码精品成人A片|
97超碰人人澡人人爱学生|
精品AV亚洲一区二区|
精品日产1区2卡三卡麻豆|
亚洲国产无线乱码在线观看|
亚洲欧美成人视频|
亚洲国产精品无码久久eeuss|
亚洲无码免费高清视频|
久久久久亚洲AV手机播放|
少妇人妻偷人精品无码视频新浪|
亚洲精品久久久WWW|
少妇做爰特黄A片免费看|
秋霞免费鲁丝片无码|
91国模少妇一区二区三区|
国产?V无码专区亚洲精品|
无码毛片内射白浆视频|
久久第一时间观看国产卡顿|
7777精品伊人久久久大香|
欧美激情a∨欧美日韩亚洲综合一区二区三区
|
日韩18视频在线观看|
成人性生交A片免费网|
波多野结衣在线观看免费区|
亚洲精品久久久久中文字幕二区|
国精产品一区二区三区有限|
亚洲国产精品无码久久一区二区
|
国内精品乱码卡一卡2卡|
无码毛片内射白浆视频|
俄罗斯娇小的学生VIDEOS16HD|
美女露全乳视频短片|
欧美性A片又大又长|
欧美人做人爱A全程免费|
67pao成人国产永久免费|
王雨纯和周于希裸乳护士|
在线观看黄色一区|
一级看片免费视频|
绿巨人app下载汅api免费视频|
亚洲精品无AMM毛片|
亚洲无人区在线观看AV|
亚洲国产货青视觉盛宴|
成人毛片女人十八|
jizzjizzjizz亚洲熟妇|
久久久久久久久久久免费精品国产|
2019中文字幕久久精品|
97精品国产高清自在线看超|
MATURETUBE乱妇|
一本大道视频大全在线|
国产麻豆一精品AV一免费软件|
久久久久久国产精品超碰|
亚洲精品卡一卡二卡3卡乱码
|
亚洲AV久久无码精品九九软件|
大香线蕉伊人久久一区二区|
调教済み変态JK扩张调教し|
亚洲色欲色欲www在线成人网|
69国产精品人妻无码免费 |
欧美三级韩国三级日本
|
少妇挑战3个黑人惨叫4P国语|
中文字幕在线视频播放不卡|
麻豆乱码1区2区新区|
99久久就热视频精品草|
国产XXXXXX农村野外|
妺妺窝人体色777777野大粗|
在线观看免费av网|
欧美性猛交XXXX乱大交3|
HEYZO无码综合国产精品|
中文字幕亚洲精品久久AV|
亚洲精品久久AV无码一区二|
免费国产作爱视频网站|
在线免播放器观看高清|
肉嘟嘟WWW视频在线观看高清|
亚洲中文久久精品AV无码|
av在线一区二区中文字幕|
一本加勒比HEZYO无码A片|
亚洲欧美国产高清|
午夜激情免费影院|
国产人妻人伦精品1国产丝袜|
成人午夜国产一区二区|
无码aⅴ精品欧美一区二区三区
|
亚洲AV久久无码精品九号软件|
久久精品国产亚洲AV蜜臀|
欧美V国产V亚洲V日韩九九|
91精品欧美久久久久久久|
青草青草久热精品视频在线百度云|
丁香婷婷色五月激情综合|
无码人妻一区二区三区潮湿|
成人啪啪高潮不断观看|
精品国产午夜福利在线观看|
欧美日韩午夜群交多人轮换|
色欲人妻AV久久无码精品|
亚洲欧美三级在线视频|
幺女幺女在线看国产毛片|
麻豆精东九一传媒在线观看|
国产高清在线观看自拍|
韩国18禁电影少女们的痛苦|
久久久久久久岛国综合免费观看|
国产乱码卡二卡三卡老狼在线观看
|
国产午夜精品视频在线播放|
做做受视频播放试看30分钟
|
日本免费在线不卡一区二区|
欧美性狂猛AAAAAA|
欧美粉嫩小泬久久久久的来源
|
公与丰满熄在线观看|
强伦轩一区二区三区四区播放方式|
人妻AV中文字幕无码专区|
激情欧美日韩一区二区|
亚洲天堂视频在线观看|
无码无遮挡刺激喷水视频|
欧美黑人添添高潮A片视频|
又黄又粗暴的gif动态图|
国产亚洲小视频线播放|
成人片黄网站色大片免费A片下载|
动漫AV纯肉无码AV电影网|
日韩美女自卫慰黄网站|
国产一级一交一乱视频|
操逼视频白浆游戏亚洲骚妇|
久久精品这里热有精品|
欧美激情A片久久久久久|
日本乱理伦片在线观看胸大|
免费无码又爽又高潮视频A|
国产一卡2卡三卡4卡免费网站|
91精品国产观看免费观看|
永久免费看A片无码播放器不卡|
色情大尺度吃奶做爰在线观看
|
亚洲中文字幕无码专区日本苍井空
|
四虎影视库免费永久视频|
97电影院成人片在线观看|
精品人伦一区二区色婷婷|
成人无码免费A片免费看软件|
福利姬液液酱高潮喷水白浆|
AV明星换脸无码精品区|
扒开腿挺进肉嫩小泬喷水网站|
国产成人91国精品|
国产剧情一卡二卡麻豆|
日韩欧美大码a在线观看|
又粗又硬又大A片黑人看片
|
A∨无码专区亚洲A∨毛片|
国精产品一区二区三区有限|
捏胸亲嘴床震娇喘视频在线播放|
AV一区AV久久AV无码|
欧洲色情三级欧美三级视频|
机机对机机手机免费下载版大全2022|
亚洲精品卡2卡3卡4卡5卡区|
国产日产欧产精品网站|
久久tv中文字幕首页|
依人在线久在线视频|
女人把腿张开叫男人桶免费视频|
99无人区码一码二码三码|
色狠狠一区二区三区熟女91|
无套内谢的新婚少妇国语播放|
人妻性奴波多野结衣无码|
国产精品成人va在线观看天堂|
被老外添嫩苞添高潮NP|
污视频欧美一区二区|
欧美肉大捧一进一出免费视频|
亚洲v无码专区国产乱码一区二区
丰满人爽人妻A片二区
|
国产在线视频在线观看一卡|
91久久夜色精品国产网站|
国产午夜中文字幕在线观看|
www.午夜色色色色av|
AV无码A片高潮AV|
欧美又黑又大AAA毛片|
午夜成人A片精品视频免费观看
|
精品成人无码一区二区久|
浪潮AV色综合久久天堂|
欧美の无码国产の无码影院|
漂亮人妻被公日日躁国产|
国产8X人视频免费观看|
婷婷综合另类小说色区|
国产精品无码久久久久2028|
国产婬A片999片免费网站|
a篇片在线观看快播|
日本xxxxxxx69xx|
午夜福利电影网站鲁片大全|
1024看片金沙人妻无码|
中文字幕2018年最新中字版|
免费的两性视频网站|
中文字乱码电影在线播放|
国产成人无码性教育视频|
AV无码AV天天AV天天爽|
麻豆国产AV尤物网站尤物|
无码无遮挡成人A片|
毛片少妇爽到高潮特黄A片|
多毛熟女HDVido多毛的简介|
久久性精品久久无码免费视频|
日韩色情图片小说AV一区|
avtt天堂网手机版亚洲|
一级a免费观看完整视频|
免费A级毛片做爰片在线|
2023国产无人区卡一卡二卡三|
国产亚洲一二三区精品免费视频观看|
91福利社试看一分钟|
一级无码婬片A片久久久自慰软件|
中文字幕丰满孑伦无码精品|
国精品产露脸偷拍视频|
日本黄H兄妹H动漫一区二区三区
|
女人?精69XXX免费网站|
国产欧美日韩另类精彩视频|
免费番肉动漫在线观看|
成人美女黄网站18禁免费|
无限在线观看播放视频高清|
国产人妻精品无码AV在线浪潮|
胖老太与人牲交BBWBBW高潮|
久久久精品久久久久久96|
中文字幕区1区3区|
男人的天堂亚洲一区二区三区|
日本无码MV免费视频在线
|
又色又爽的无遮挡免费网址|
蜜臀av性久久久久蜜臀aⅴ流畅|
97久久国产露脸精品国产|
一本在线不卡免费视频|
在线不卡日本v二区到六区|
亚洲AV成人影视在线观看|
北条麻妃视频在线|
9l情侣在线精品国产|
亚洲一品AV片观看五月色婷婷
|
国产免费AV片在线播放唯爱网|
自拍偷拍亚洲视频中文字幕|
香港经典av三级观看|
又大又爽欧美AAAA片免费|
亚洲一区二区三区四区五区六|
一区二区三区毛A片特级|
久久久久久综合七次郎|
老头边吃奶边弄进去呻吟|
在教室伦流澡到高潮HGL动漫|
扒开老师大腿猛进AAA片邪恶
|
91精国产品一区二区|
jizzjizzjizz亚洲熟妇|
成人美女黄网站18禁免费|
日韩专区亚洲精品视频在线观看|
3344com.成年站|
性一乱一交一A片.看A片|
秋葵APP下载汅API免费麻豆色多多|
国产美女一级做a爱视频|
国产福利资源网在线观看|
国产成人无码免费看片软件|
亚洲国产二区三区久久|
欧美性videos高清精品|
麻豆av一区二区三区|
成视频年人黄网站免费视频|
久久精品视频在线看4|
国产成人se在线播放|
极品少妇被后入内射视|
亚洲日韩国产精品乱|
久久国产精品免费观看|
国产1988精品A片|
成人在线观看国产一区|
日韩女优一区二区三区|
亚洲精品久久无码AV片麻豆|
国产下药迷倒白嫩丰满美女BD|
欧美激情A片久久久久久|
日韩精品一卡2卡3卡4卡新区|
粗大的内捧猛烈进出A片黄|
丰满放荡岳乱蜜桃AV|
成人无码区精品一区二区不卡亚洲
|
欧美激情无码一区二区三区明星|
北条麻妃视频在线|
少妇成熟A片无码专区小说|
精品国婬伦v无码久久久|
在线视频免费观看爽爽爽|
真人做爰欧美AAAAA|
99热久久是有精品首页|
18禁宅男深夜免费网站无码|
亚洲精品无码高潮喷水A片小说|
欧美丰满熟妇BBB久久久|
色情免费100部A片看片|
免费区大尺码体验区|
亚洲高清最新av网站|
国产人妻精品无码AV在线浪潮|
99久久免费看少妇高潮A片特黄|
亚洲欧美韩国综合色|
最新国产精品视频每日更新
|
国产成人无码精品AV在线蜜臀|
最新国产一二三区无码|
成人区精品一区二区婷婷|
精品免费A片一区二区久久|
豪妇荡乳1一5杨贵妃|
成人免费A片视频在线观看网站|
三级成人AV电影在线观看|
东北乱子伦精彩对白|
777精品久无码人妻蜜桃|
久久精品国产亚洲AV蜜臀|
成人性生交A片免费看网站|
欧美午夜精品一区二区三区电影
|
成人国产一区二区精品小说|
精品午夜福利无人区乱码一区|
2023国产无人区卡一卡二卡三|
无尺码精品产品视频|
亚洲熟妇av一区二区三区色堂|
欧美精品狠狠色丁香婷婷|
亚洲一卡二新区乱码绿踪林|
中文字幕日韩精品有码视频|
有人有看片的资源吗WWW在线|
朋友人妻翘臀迎接我粗大撞击|
青青草原亚洲精品在线观看|
亚洲国产精品成人综合久久久|
国产性爱在线观看亚洲欧美性爱视频|
麻豆爽爽妓女一区二区三区|
91午夜福利在线观看一区二区|
卡一卡二卡三在线入口十八岁|
国产传媒免费看A片|
两人做人爱视频试看在线观看|
www.夜夜撸.com|
欧美自拍嘿咻内射在线观看|
高清国产人妇牲交视频|
粗大的内捧猛烈进出A片黄|
精品麻豆一卡2卡三卡4卡乱码
|
成人黄网站A片免费观看|
久久久久成亚洲综合精品|
人妻被别人巨茎征服的后果|
91精品久久久久久久久中文字
|
国产Av影片麻豆精品传媒|
国产高清精品国语特黄A片|
亚洲精品电影天堂网|
亚洲 自拍 欧美 小说 综合|
精品国产国产综欧美国产亚洲日韩|
精品无码欧美一区二区三区不卡|
草莓视频在线观看网址 |
久久久久亚洲AV无码AV男人
|
2014av手机天堂网免费|
国产精品机视频大陆|
人妻少妇被粗大爽9797PW|
69国产精品人妻无码免费 |
色一情一乱一乱一区99AV|
大香线蕉伊人久久一区二区|
艳妇荡岳丰满交换做爰电影|
成人免看一级a一片A片|
中文日产幕无线码一区2021|
一本色道久久亚洲AV蜜桃|
欧美又大又黄又粗又长A片|
999国产精品欧美一区二区 |
亚洲精品91一区二区三区|
久久99热人妻偷产国产|
真人老太婆一级A片免费|
天美传媒色情原创精品|
忘忧草一卡二卡三卡|
国产一区二区女内射|
国产人妻精品无码AV在线浪潮|
亚洲熟妇av一区二区三区色堂|
精品亚洲国产熟女福利自在线|
无码又黄又爽又舒服的A片|
四虎在线永久免费国产精品資源免費看|
内射无码专区久久亚洲|
国产传媒18精品A片在线观看|
无码人妻av一区二区三区蜜臀|
北条麻妃jul一773在线看|
成人午夜激情视频免费观看
|
成人午夜国产一区二区|
国产成人精品a视频三区|
国产高潮抽搐在线观看|
亚洲国产精品成AV人不卡无码|
日韩成人A片高潮猛叫农村妇女|
欧美又大又粗又湿A片|
国产午夜精华精华精华婷|
漂亮人妻被公日日躁国产|
青青草国产97免费观看|
www.插插插.com|
日本乱妇乱子视频网站-百度|
成av人电影在线观看|
睡熟迷奷系列新婚之夜|
日本乱妇18日本乱妇18p|
亚洲国产精品成人综合久久久|
日韩少妇人妻喷潮湿无码视频
|
自拍h视频一区二区|
欧美成人精品无码网站|
麻豆 天美 果冻 星空国产|
99国产婷婷综合在线视频|
97久久国产露脸精品国产|
FREE性丰满白嫩白嫩的HD|
99麻花传媒剧国产免费|
4HU影库最新永久地址入口|
东京热无码中文字幕av专区|
亚洲卡二卡三无线乱码新区|
福利日木AV无码专区亚洲AV毛片|
精品卡一卡二乱码新区|
日韩中文亚洲欧美视频二|
国产精品无码久久久最先观看|
中文乱码一线二线三线|
caoprom最新超碰地址|
大战熟女丰满人妻AV|
果va传媒在线看冻v|
亚瑟国产精品久久无码|
一本加勒比HEZYO无码A片|
国产精品无码久久蜜臀av|
入室强伦轩人妻电影|
AV天堂午夜精品一区|
日本一本二本无码免费视频|
苍井空A级在线观看网站|
2019中文字乱码字幕100页|
亚洲精品一区三区三区在线观看
|
日韩精品一区二区?v在线|
久久女人被添全过程A片|
男人的天堂亚洲一线AV在线观看
|
欧美性插B在线视频网站|
av天堂天堂久久久av不卡|
国产美女高潮福利|
www.色情.com|
两个吃上面一个人下试看|
国产.日韩.欧美激情视频 |
亚洲熟女乱色综合亚洲小说|
噜噜AV亚洲一区二区|
亚洲午夜久久久久久国产精品
|
在线精品一卡乱码免费|
www.834.com.成人片|
无码日日爽夜夜爽|
成全影视在线观看国语|
欧美日韩中文在线播放专区|
乱公和我做爽死我了A片|
国产又色又爽又免费的刺激软件|
妺妺窝人体色777777野大粗|
在教室里揉老师的胸动态图|
99麻花传媒剧国产免费|
亚洲久婷天堂无码Av在线|
日韩精品一区二区亚洲AV观看|
AV天堂久久天堂色综合 |
97网站免费看国产视频|
日韩AV爽爽爽久久久久久|
中文字幕一区二区三区人妻在线视频
|
夫の前で痴汉に绝顶人妻国产剧|
无码国模国产在线观看|
果冻传媒人妻国产精品苏畅|
99在线精品免费视频|
丁香五月香婷婷五月|
试看免看一级a一片|
日日摸夜夜添夜夜添A片牛牛影视
山东熟妇高潮大炕嗷嗷叫视频
|
国产精品无码久久蜜臀av|
sao虎影院桃红视频在线观看|
亚洲天堂2017无码|
12一14性xxxxx国外|
huan色大片电影百度影音|
午夜福利电影网站鲁片大全|
午夜三级av在线播放
|
欧美S码亚洲码精品M码|
最近MV中文字幕国语免费|
两个人免费视频观看高清直播下载|
久草在线草a免费线看|
麻豆精品传媒一二三区|
国产又粗又长又黑的A片国产|
机机对机机手机免费下载版大全2022
|
中文字幕一区视频一线|
国产卡一卡二卡3卡4乱码|
卡一卡二卡三在线入口十八岁|
最近更新中文字幕手机版|
五月丁香综合啪啪成人|
亚洲欧美乱色情图片|
波多野结衣亚洲一二三|
国产成人A片免费观看|
18禁免费久久久久久久|
歪歪爽蜜臀AV久久精品人人槡|
麻豆蜜桃丝瓜绿巨人糖心秋葵|
果冻传媒人妻国产精品苏畅|
国产精品白丝jk喷白浆软件|
少妇av色欲无码人妻精品|
9966国产精品视频|
五月六月丁香婷婷激情|
亚洲情综合五月天|
日韩一卡2卡3卡4卡乱码网站导航|
日本又黄又爽又色又刺激的视频|
欧美日本在线免费观看|
最好看的2018中文字幕国语|
国产.日韩.欧美激情视频 |
国产999精品2卡3卡4卡
|
中文字幕亚洲中文精品乱码在线|
中文乱码一线二线三线|
拧花蒂尿用力按凸起喷水尿一区|
最新一本到2019线观看|
在线不卡日本v二区到六区|
一本无码中文字幕不卡|
国产一区二区无码精品小说
|
一本久道视频无线视频|
老头下边又粗又大又硬|
最近免费的中文字幕一|
青柠社区在线观看免费完整版|
新67194成在线入口|
XUNLEIGE在线观看|
国产av巨作情欲放纵无码下载|
男女两性做爰全过程A片|
一本道不卡中中文无码|
成人做爰高潮尖叫声免费观看|
av网站久久桃色
|
国产老熟女伦老熟妇视频|
国产精品亚洲蜜臀无码|
少妇特黄A片一区二区三区免费看|
日韩一区二区三区无码|
色情爱视频网站免费观看|
97电影院成人片在线观看|
国产熟妇搡BBBB搡BBBB|
亚洲成人黄色网址|
成人美女黄网站18禁免费|
四川少妇bbbbbbbw|
最近中文字幕电影免费MV|
欧美の无码国产の无码影院|
男人大JI巴做爰呻吟视频男男|
久久精品女人天堂|
日韩欧美中文字幕在线点播|
女人?精69XXX免费网站|
四虎影视库免费永久视频|
成人黄色小视频在线观看|
国产精品毛片AV999999|
亚洲精品无码高潮喷水A片小说|
www.亚洲天堂|
一边喂奶一边挨CAO|
男人大JI巴图片(裸)|
黄污色污国产高清无码在线观看
|
99久久国产综合精麻豆|
97人妻久久久精品系列A片
|
91精品视频在线|
少妇无码吹潮久久精品AV网站|
亚洲性线免费观看视频成熟|
久久夜色精品国产欧美乱极品|
69式国产真人免费视频|
又大又硬又粗做大爽A片无册
|
啊灬轻点大JI巴太粗又长A片
|
亚洲天堂2017无码|
亚洲AV综合AV国产AV|
扒开老师粉嫩的泬10P|
一本道久在线综合色色|
中文字幕一区二区在线2021|
奶头好大狂揉60分钟视频|
精品视频在线观看|
一本大道视频大全在线|
久久久久久国产精品超碰|
香蕉AV福利精品导航|
久久频这里精品99香蕉久网址|
成人片黄网站A片免费
|
被黑人伦流澡到高潮HN小说|
最近中文字幕完整版2019免费|
极品媚黑91黑人在线播放|
日日夜夜爱爱鲁鲁舔舔
|
亚洲AV成人无码久久精品麻豆|
a级全黄试频试看30分钟|
AAA美女免费在线观看|
大香线蕉伊人久久一区二区|
午夜精品成人一区二区视频|
av手机在线观看一区二区三区|
9l情侣在线精品国产|
超碰无码精品一区二区三区|
WWW色视频片内射|
蜜色欲多人AV久久无码|
中文字幕乱码一区AV久久
|
日韩在线精品中文字幕一区二区|
人妻精品人妻无码一区二区三区|
1区2区3区产品乱码免费|
亚洲婷婷六月丁香|
日产乱码卡一卡2卡三卡四福利|
午夜精品电影高清完整版|
日本理论片强奷AA片|
亚洲AV久久久噜噜噜久久|
欧美又黑又大AAA毛片
|
少妇无码吹潮久久精品AV|
国产日韩免费无码一区二区|
一本大道视频大全在线|
福利一区三区国产在线视频|
99久久免费国产精品热|
四川少妇ddd凸凸凸ddd|
后入白嫩网红内射99XYZ|
国产精品一区二区AV97|
亚洲精品91一区二区三区|
撕开奶罩揉吮奶头A片久久下载|
乱熟女高潮一区二区在线|
国产精品583一区二区免费看|
国产精品久久久久一区二区三区共|
欧美激情a∨欧美日韩亚洲综合一区二区三区
|
国产精品久久久久久久久久两年半|
97无码精品二区在线视频|
日韩精品无码一区二区免费A片|
69SEX久久精品国产麻豆|
av中文字幕在线天堂网|
成人亚洲天堂av在线|
乱码午夜-极品国产内射|
久久久久亚洲AV无码AV男人
|
91久久夜色精品国产网站|
国产精品583一区二区免费看|
亚洲精品伦理熟女国产一区二区|
熟岳大屁股疯狂迎合|
女人18毛片a级毛片|
一区二区三区内射美女|
91午夜日韩在线观看免费|
91精品国产蜜臀在线观看|
免费人成视频X8X8入口观看大|
国产性一乱一性一伧下载|
真实国产精品视频国产网|
日韩亚洲产在线观看|
久久视频在线视频2019|
天堂网WWW最新版|
国产免费又爽又色又粗视频|
国产浮力草草影院CCYY|
久久精品国产亚洲AV蜜臀|
亚洲欧美高清无码专区|
无码缴情做A爱片毛片A片|
99久久精品国内|
大陆色情免费视频观看|
我和丰满老师疯狂做爰在线观看|
波多野结衣一本道在线|
成人做爰WWW网站视频|
最近更新中文字幕第一页|
亚洲中文字幕婷婷在线|
国精品无码一区二区三区左线|
免费做爰猛烈吃奶摸视频在线观看|
黑人大荫道BBWBBB高潮潮喷|
午夜67194二线路|
无码人妻精品一区二区蜜桃漫画|
99久久国产露脸精品国产麻豆|
调教超级YIN荡玩物学生H|
少妇被多人C夜夜爽爽|
成人啪啪爽到潮喷喷水水|
久久久2019精品视频在线播放|
91正在播放极品白嫩在线观看|
精品日产免费观看视频|
午夜dj在线观看免费视频www|
97人妻超在线观看免费|
2023海角最新回家路|
A片人澡C片人人妻|
无码无遮挡成人A片|
麻豆精东九一传媒在线观看|
疯狂揉小泬到失禁高潮AV|
亚洲狠狠久久综合一区二区三区
|
亚洲精品免费在线|
国内精品一卡二卡三卡公司|
99在线视频观看|
精品无人区卡一卡二卡三|
熟妇的味道HD中文字幕|
婷婷亚洲综合小说图片|
岛国精品无码少妇在线|
惠民福利无码少妇精品一区二区免费动态
|
姝姝的白丝又湿又紧|
成人黄色小视频在线观看|
成人无码区免费A片视频WWW|
成人女人爽到高潮的A片羞羞动漫
中文字幕在线视频永久
|
四川少妇ddd凸凸凸ddd
|
中文国产乱码在线人妻一区二区|
日本欧美激情在线观看|
精品国产sm在线大全|
国产高清色情在线观看APP|
色一情一乱一乱一区99AV|
精品国产粉嫩内射白浆内射双马尾|
天堂最新版在线中文|
校花夹震蛋上课爽死H女女|
亚洲欧洲成人精品AV97|
国产午夜精品一区理论片飘花|
MATURETUBE乱妇|
伊人亚洲AV久久无码精品|
五月丁香激情综合亚洲麻豆精品|
999亚洲精品无码久久久久|
丰满少妇高潮惨叫在线观看|
在线观看免费av网|
欧美性猛交XXXX乱大交3|
中文字幕aⅴ一区二区三|
HEYZO中文字幕无码|
四川少BBB搡BBB爽爽爽|
精品无码人妻一区二区三区色
|
97狠狠擼97狠狠擼视频|
欧美S码亚洲码精品M码|
97精品国产高清自在线看超|
国产精品国产三级国AV在线观看|
12一14性xxxxx国外|
日本精品无码一区二区三区久久久|
豪妇荡乳1一5杨贵妃|
三级成人AV电影在线观看|
免费主播福利视频韩国日本|
美女被后入在线视频网站|
免费区大尺码体验区|
亚洲成人黄色网址|
巨爆乳肉感一区二区三区视频|
免费鲁丝无码下属一级|
欧美精品一区二区三区A片|
龙欲h粗喘强占公妇H|
亚洲精品拍拍央视网出文|
久久大香伊蕉在人线免费|
又黑又粗又大的欧美A片|
亚洲熟女乱色综合一区小说|
人妻久久久精品99系列A片毛|
男人天堂网2018最新地址|
99精品人妻无码专区在线视频区|
国产人妻午夜在线无码|
国产精品人妻无码免费A片导航|
午夜成年奭片免费观看|
拔擦拔擦8X永久华人免费播放器|
久久人人爽爽人人爽AA片|
免费观看成人毛片A片2008|
2019国产在线|
激情欧美性AAAAA片|
JVID亚洲精品无圣光图套|
两人做人爱视频在线观看|
国产精品一色一情一伦|
午夜福到在线4国产|
无码人妻视频又大又粗欧美|
亚洲精品无码高潮喷水A片小说
|
JVID亚洲精品无圣光图套|
99久久综合精品五月天 |
无遮无挡试看120秒高潮|
精产国品少妇在线视频|
东京热男的天堂av|
97网站免费看国产视频|
欧美精品久久久久久无码人妻|
国产熟妇肥臀多毛BBW|
西西444WWW无码视频男男|
欧洲老妇60一70|
无码无遮挡成人A片|
美女又爽又黄视频|
日韩一级电影在线|
日本高清h色视频在线观看|
日本一级特黄大片AAAAA级|
一本大道高清香蕉中文大在线|
青青草视频在线观看免费|
成人无码A片视频播放|
捏胸亲嘴床震娇喘视频在线播放|
精品无码人妻一区二区三区视频|
国产日韩精品视频一区二区三区|
中文字字幕在线中文乱码2019|
啊轻点灬公大JI巴又大又|
午夜播放器在线观看|
麻豆国产成人AV在线|
99热这里只有精品9|
免费观看a毛片一区二区不卡|
91 国语精品自产拍在线观看|
免费永久观看美女视频网站网址
|
波多野结衣一本道在线|
777色情在线无码|
又硬又粗进去爽A片免费无码
|
一起碰一起噜一起草视频|
免费A级毛片在线播放不收费|
欧美A级肉欲大片XXX|
国产成人精品亚洲精品一区色欲|
青青青国产精品一区二区|
国产在线视频在线观看一卡|
夜夜噜2017最新视频|
精品国产露脸久久AV麻豆|
欧美激情精品久久久久久大尺度|
调教済み変态JK扩张调教し|
国产激情黄A片无遮挡|
黄色肉网站免费在线观看|
亚洲 自拍 欧美 小说 综合|
久久第一时间观看国产卡顿|
不充会员的爽爽影院|
日本老妇一级特黄aa大片|
青柠社区在线观看免费完整版
|
毛一卡二卡三卡免费看|
免费观看黄色a一级视频播放|
91超碰久久精品一区二区|
小受O被摁着扒开C嗯合不拢腿|
免费全部黄A片免费播放|
欧美又粗又大又爽又色A片|
99热在这里只有免费精品|
亚洲欧美色国产综合|
极品人妻VIDEOSSS人妻|
精品亚洲一区二区三区在线播放|
日韩做A爰片久久毛片A片毛茸茸|
国产精品1卡二卡三卡四卡乱码|
HEYZO无码综合国产精品|
成人午夜AV亚洲精品无码网站|
18美女裸免费观看网站|
最新欧美精品一区二区视频|
日韩AV无码一区二区三区不卡毛片|
999国内精品永久免费观看|
国产亚洲精品中文带字幕21页|
波多也结衣无码精品AV|
摸BBB揉BBB添BBB|
男人天堂网夜色99视频|
日韩人妻无码精品A片免费不卡|
99久久精品国产免费|
国产亚洲综合一区柠檬导航|
国产精品一区二区 尿失禁|
日本一道人妻无码一区视频|
河北全程露脸对白自拍|
少妇真实被内射视频三四区|
精品无人区麻豆乱码1区2|
国产毛片女人高潮叫声|
5月丁香婷婷网俺来也|
精品久久久爽爽久久久AV|
亚洲国产主播精品二区|
把舌头伸进去添我的批真舒服视频|
超爽超碰人人做wwwcom国产|
久久精品一区二区三区不卡牛牛
|
国产成人AV大片大片在线|
爱如潮水免费视频播放
|
影音先锋av最新资源站|
色偷偷男人的天堂a v|
97久久久精品综合88久久|
中文国产乱码在线人妻一区二区|
精品日韩二区三区精品视频|
人妻AV中文字幕无码专区|
欧美特级特黄AAAAA片|
欧美高清在线视频一区二区|
少妇一级黄色婬片免费看|
亚洲性线免费观看视频成熟|
中文字幕亚洲男人的天堂网络|
成人欧美一区二区三区白人|
色情推油按摩G点高潮无码视频|
亚洲午夜精品A片久久W|
成年美女黄网站色大免费全看|
麻豆一区二区三区蜜桃免费
|
亚洲AV成人影视在线观看|
日韩丰满少妇无吗视频激情内射
|
Free HD XXXX DH 69|
狠狠色丁香久久婷婷综合图片|
无码无遮挡成人A片|
在线观看不卡av电影|
四季AV一区二区三区在线在线观看|
日韩精品欧美视频|
在线观看肉片H漫网站|
老头边吃奶边弄进去呻吟|
羞羞影院午夜男女爽爽影院网站|
国产精品人成A片一区二区|
亚洲AV秘无码一区二区三竹菊|
少妇风韵犹存偷拍视频一区|
日本无码人妻精品一区二区蜜桃|
一本二本三本AV亚洲电影|
狼群视频在线观看免费完整版|
丰满少妇呻吟高潮经历|
成人片黄网站A片免费|
手机午夜电影神马久久|
天天影视亚洲综合网|
边做边爱免费看视频|
jizzjizz直播|
四虎在线永久免费国产精品資源免費看|
99九九99九九九视频精品|
国产精品视频男人的天堂|
校花裸体扒开两腿让我桶|
夫妻互换精品三级国产 |
成人无码高潮AV在线观看|
久久无人区卡三卡4卡|
日本添下边无码视频|
菠萝菠萝蜜菠萝菠萝蜜7麻豆|
激情内射人妻1区2区3区|
国产亚洲精品福利视频|
大肉大捧一进一出视频出来呀视频社区在线|
无码日本少妇精品视频|
青青草在在观免费1|
亚洲精品久久久久无码精品|
无人区乱码一线二线忘忧草|
大尺度一对一视频聊天APP 2019|
高清无码视频在线播放|
波多野42部无码喷潮在线|
天天躁日日躁狼狼超碰97|
超级婬乱人妻av无码|
国产av丝袜熟女丰满一区二区
|
果冻传媒国产仙踪林
|
被黑人伦流澡到高潮HN小说|
曰本人做爰大片免费观看一|
亚洲国产欧美日本视频|
亚洲精品久久久久久久久久飞鱼
|
亚洲精品AV无码喷奶水糖心|
亚洲欧美一区二区三区九九九|
性夜黄A片爽爽免费视频|
日韩AV无码一区二区三区不卡毛片|
国产又黄又刺激的免费A片小说|
真人做爰高潮全过程毛片|
乱理片 最新乱理片2018|
萝莉社动漫在线观看|
好硬啊一进一得太深了A片69|
激情aa视频试看免费|
亚洲卡二卡三无线乱码新区|
亚洲外露出全裸福利网站频道|
亚洲精品久久婷婷丁香51|
免费啪视频在线观看视频日本|
日本一卡二卡3卡四卡网站精品|
波多野结衣作品番号|
亚洲国产精品成人精品A片|
www.亚洲天堂|
国产成人a在观看网站国产成人
|
国产又爽又大又黄A片图片|
国产白丝无码视频在线观看|
精品人伦一区二区三区潘金莲|
免费全部黄A片免费播放|
国产乱码卡二卡三卡4
|
日本乱理伦片在线观看胸大|
国产精品自在自线亚洲|
成人乱人乱一区二区三区|
亚洲A片一区日韩精品无码|
国产二级一片内射视频插放|
国产艳妇AV在线观看果冻传媒|
成年人午夜激情黄色视频
|
亚洲午夜无码精品福利在线看
|
一区国产传媒国产精品|
麻豆传煤入口免费进入2023|
被老外添嫩苞添高潮NP|
91美女秘 片黄在线观看|
浪潮AV色综合久久天堂|
永久午夜福利视频一区在线观看|
国产美女做爰A片免费|
王局长把乳罩解开吃胸的动态图
|
精品免费A片一区二区久久|
被操高潮受不了视频|
国产无套视频在线观看香蕉|
嫩草影院一二三区入口首页
|
91网页在线浏览|
国产精品AV国片偷人妻麻豆
|
日本A片大尺度高潮无码|
成人天堂婷婷青青视频在线观看
|
国产久热在线观看视频|
无码中文字幕在线播放2|
激情亚洲欧美综合精品二区|
FREE性开放小少妇|
国产熟妇乱子伦hd|
精品乱码一二三四区别|
女性奴跪爬伺候调教虐|
国产精品国产三级国产AⅤ中文|
成人精品视频99在线观看免费|
黄污色污国产高清无码在线观看
|
国产成人精品日本亚洲11|
日本一区二区在线视频观看|
精品一区成人免费看片视频吗|
把女人弄爽A片特黄大片在线|
香蕉视频三级强奸|
国产对白精品刺激一区二区|
午夜福利电影网站鲁片大全
|
97电影院成人片在线观看|
国产卡二卡三卡四乱码分类|
欧美一区二区三区久久综|
222com奇米第四色|
91av视频免费在线观看|
97在线观看在线观看|
国产成人91国精品|
亚洲日韩国产精品乱|
999久久狠狠免费精品|
亚洲色偷精品一区二区三区|
搡女人真爽免费视频网站|
国产亚洲精品久久77777
|
国产一级性爱视频|
国产av丝袜熟女丰满一区二区 |
啊轻点灬大JI巴又大又粗|
日本无码一区二区三区不卡毛片|
欧美日产成人高清视频|
国内精品一卡二卡三卡公司|
国产精品人妻无码久久久竹菊影视|
国产毛2卡3卡4卡视频免费|
国产精品扒开腿做爽爽爽A片唱戏|
99久久免费看少妇高潮A片特黄|
欧美性潮喷XXXXX无码|
在线精品免费视频中文字幕|
影音先锋成人电影在线|
国产乱码卡二卡三卡4|
成人做爰视频WWW网站|
91福利国产在线观一区二区|
久久精品香蕉绿巨人登场|
精品无人无码乱码毛片国产小说
|
国产av巨作一区二区三区|
国产gv在线观看受被做哭|
av在线免费看网站|
亚洲精品久久久久中文字幕二区|
AV无码AV天天AV天天爽|
无码欧美又大又色又爽AAAA片|
丰满人妻妇伦又伦精品国产|
一级无码婬片A片久久久自慰软件|
欧美又黄又嫩大片A片|
国产精品jizz在线观看软件|
沈阳熟女露脸对白视频|
www.亚洲天堂|
亚洲国产色情在线观看|
嗯灬啊灬把腿张开灬A片视频网站|
色一情一乱一乱一区99AV|
日产乱码一区二区三区在线|
日产一卡2卡三卡乱码在线下载|
丁香综合缴情六月婷婷 |
国产美女精品a在线鸭王|
中文字幕无线码中文字幕下载|
国产SUV精品一区二妻|
99噜噜噜在线播放|
免费看欧美成人A片无码|
无人区码卡二卡1卡2卡在线|
美女又爽又黄视频|
久久九九少妇免费看A片|
黄色激情在线观看|
男人的天堂亚洲一区二区三区
|
色狠狠一区二区三区熟女91|
三男挺进一女爽爽爽小说|
日本少妇无码一区视频|
日本三级黄线在线播放|
无码人妻一区二区三区免费京洛会|
色又黄又爽18禁免费视频|
蜜臀久久AV无码牛牛影视|
久久久国产人妻精品|
欧洲无码精品a区无人码|
嫩BBB槡BBBB槡BBBB18|
成人网站A片色情免费观看|
国产脚交视频在线观看|
免费人成在线观看网站品爱网
|
丰满老妇农夫69小说|
色欲AV亚洲A片永久无码精品|
久久精品无码欧美成人一区|
色欲精品国产AV久久久|
一级无码婬片A片久久久自慰软件|
人妻久久久精品99系列A片毛|
ZOZOZO另类人禽交|
男女高潮又爽又黄又无遮挡|
亚洲欧美中文字幕高清在线
|
激情区小说区偷拍区图片区
|
把舌头伸进去添我的批真舒服视频|
91久久国语露脸精品国产高跟
|
乱码卡一卡二新区网站|
日日碰狠狠躁久久躁综合网
|
欧美日韩不卡视频在线|
成人欧美一区二区三区A片|
WWW.色噜噜.COM|
中文字幕亚洲专区无码|
亚洲无线看天堂av|
亚洲一区二区在线aⅤ|
在线人成亚洲播放网站|
动漫AV网站免费观看|
国产天堂AV在线色|
人妻被中出不敢呻吟A片视频|
肥婆巨肥BBBwBBBwBBW|
www.久久精品视频|
A片太大太长太深好爽A片视频|
免费又黄又爽A片免费看|
欧美乱熟人妻色情影视|
国产精品悠悠久久人妻精品|
日韩亚洲福利网站|
亚洲老司机成人精品影院|
精品国产无码日韩一三区|
99精品视频在线观看婷婷|
jiucao在线观看精品|
一卡二卡3卡四卡网站精品|
久久天天婷婷五月俺也去|
亚洲卡二卡三无线乱码新区|
午夜成人A片精品视频免费观看|
欧美荫蒂添的好舒服A片|
97色伦婷婷综合色情网|
久久免费国产精品|
亚洲国产精品无码久久久久久久久
|
入室强伦轩人妻电影|
萝莉社动漫在线观看|
蜜臀久久AV无码牛牛影视|
精品久久免费视频|
一区青椒午夜剧场|
日本一本道在线一二区
|
欧美在线日韩精品国产另类|
久久亚洲精品无码观看|
内射爽无广熟女亚洲|
好硬啊进得太深了A片无码视频|
av五月天不卡网|
蜜桃臀无码内射一区二区三区|
久久这里的只有是精品23|
最近2019免费中文第一页|
午夜色情A片成人免费视频下载|
免费?V片在线观看蜜芽TV|
美女露全乳视频短片|
国产在线播放KKK|
chinese熟女熟妇m1f|
国产又色又爽又黄的男女小说免费|
王雨纯和周于希裸乳护士|
久久99精品国语久久久|
欧美阿v高清资源在线|
国产高清无码一区二区|
2017中文字字幕66页|
女人被添全过程A片试看|
国产日产人成人A片AA|
一起碰一起噜一起草视频|
吃奶呻吟打开双腿做受是免费视频|
欧美黑人巨大xxxxx|
国产av丝袜熟女丰满一区二区 |
亚洲中文字幕永久在线全国|
国产伦精品一区二区免费|
舌头添高潮A级毛片|
午夜色情A片成人免费视频下载
|
少妇刮伦人妇A片1级|
一本大道一卡二卡三卡乱码|
人妻无码AV中文系列免费|
国产精品亚洲综合久久综合亚洲鲁鲁五月天|
亚洲AV久久无码精品九九小说|
黑人与人妻无码中字视频|
97超人人澡不卡|
av色国产精品喷浆|
特级黄色一级片免费观看视频|
WWW国产亚洲精品久久麻豆|
91网页在线浏览|
丝袜脚夹住上下摩擦榨精|
高清一区二区三区免费视频|
亚洲国产精品成人久久久软件|
秋葵APP下载汅API免费麻豆色多多
|
丰满岳妇乱一区二区三区|
国产精品免费小视频|
18禁外国精品久久久久久|
中文字幕亚洲码 在线观看|
国产二区日韩AV制服丝袜|
榴莲视频下载APP|
日产精品一二三区0.0.0.0|
国产 欧美日韩专区|
韩国乱码卡一卡二4399|
WBBBB搡BBBB搡BBBB|
果冻传媒人妻国产精品苏畅|
国产日产人成人A片AA|
国产精选莉莉私人影院|
国产精品大陆偷拍视频|
91无码人妻精品一区二区蜜桃|
五月婷婷开心中文字幕|
熟女人妻のAV中文字慕|
四虎影库884aa.www223|
又黄又爽又无遮体的A片|
aa电影无码国产|
窝窝看一夜七次郎在线视频|
www.插插插.com|
国产精品亚洲蜜臀无码|
无码潮喷A片无码高潮小说|
乱码一区二区三区竹菊|
巨肉超污巨黄H文小短文|
欧美熟女人妻一区二区三区
|
国产做爰又粗又大又爽动漫|
爱作爱无码视频在线观看 |
337p日本欧洲亚洲大胆精品555588|
无敌神马影院视频观看高清免费|
亚洲最大成人色情图片|
国产人妻久久精品一区二|
乖乖女从小被C到大H补课1视频|
好紧我太爽了视频免费国产|
無码一区中文字幕少妇熟女|
国产三级片视频在线观看|
毛片黄片免费播放|
影音先锋成人电影在线|
免费AV岛国大片在线观看|
任你搞视频这里只有精品|
麻豆果冻传媒在线观看|
国产va免费精品观看精品黄片 |
免费乱理伦片在线观看夜|
国产精品久久人妻无码蜜|
一本色道久久亚洲AV蜜桃|
欧美黑人添添高潮A片视频|
久久午夜无码鲁丝片午夜精品|
亚洲精品白浆高清久久久久久|
2020年最新国产精品正在播放|
久久免费看少妇高潮A片麻豆|
成人Av一本不卡二卡|
精品无码欧美一区二区三区不卡|
最近中文字幕MV免费视频|
无人区在线日本高清免费|
2019最新国产不卡a国内2018|
亚色九九九全国免费视频|
91精品国产综合久久久久久一区黄网无码
|
免费观看a毛片一区二区不卡|
国产亚洲精品成人AA片在线播|
成全久久免费高清大全AV|
女人爽到喷水的视频大全在线观看
|
国产麻豆9l精品三级站|
欧美丰满少妇久久无码精品|
捏胸亲嘴床震娇喘视频在线播放|
真实国产精品视频国产网|
国产农村野外A片性视频|
人妻久久久精品99系列A片毛|
一级黄色香蕉视频|
99久久久无码国产精品免费蜜柚|
亚洲无码精品推荐|
偷偷与邻居做爰完整视频|
天天综合网在线观看视频|
成人精品在线一区二区三区|
蜜桃一区二区在线视频|
嗯 用力啊 嗯 c我 啊哈老师|
日本A片大尺度高潮无码|
日本A级做爰午夜免费视频|
麻豆视传媒短视频的服务行业|
日日噜噜大屁股熟妇|
欧洲一区二区三区网站|
亚洲色婷婷婷婷五月|
国产成人91国精品|
欧美视频无砖专区一中文字目|
av中文字幕亚洲 |
jizz中国免费在线播放麻豆视频|
国内卡一卡二卡三免费网站|
中文字幕亚洲欧美日韩2019|
毛茸茸老太BBWBBW|
亚洲欧美国产高清|
日本一道人妻无码一区视频
|
久久精品国产亚洲av蜜色|
国产做A爱免费视频在线观看|
国产精品7777人妻精品冫
|
女人色国产a精品|
多毛熟女HDVido多毛的简介
|
91久久国语露脸精品国产高跟
|
17C一起草在线观看入口|
MATURETUBE乱妇|
9966国产精品视频|
色翁荡熄系列白洁2|
国产精品一区二区在线播放|
国产又粗又猛又黄又爽无遮挡|
又黄又爽又无遮挡在线观看免费|
亚洲av无码日韩av无码|
成人一区二区三区免费观看
|
最新亚洲精品成人在线|
久久大香伊蕉在人线免费|
麻豆高潮AV久久久久久久|
www亚洲国产成人|
国产18禁黄网站免费观看|
无码做爰全过程免费的床震|
亚色九九九全国免费视频|
激烈18禁高潮视频免费|
人妻被下春药中文字幕|
成人高潮片免费视频吃奶|
99精品又大又爽又粗少妇毛片|
黑人猛交一二三区A片R|
亚洲AV无码网站yw尤物|
日本xxxxxxx成年动漫|
亚洲一品AV片观看五月色婷婷|
丰满人妻妇伦又伦精品国产|
动漫精品一区二区在线观看|
最好免费观看高清视频直播小说|
夜夜穞天天穞狠狠穞AV美女按摩|
乱色熟女一区二区三区1000部|
国产XXX69麻豆国语对白|
精品麻豆一卡2卡三卡4卡乱码|
免费无码又爽又黄又刺激网站|
男人天堂网夜色99视频|
欧美dodk巨大HD|
亚洲AV小说最新在线网址|
大尺度一对一视频聊天APP 2019|
欧美高清性xxxxxxx|
高潮精品视频国产|
四川少妇BBB凸凸凸BBB安慰我|
中文字幕在线不卡视频蜜乳|
97久久久精品综合88久久|
亚洲国产综合久久久久|
日本添下边无码视频|
亚洲永久精品AV在线观看|
久久免费香蕉视频观看|
国产Av影片麻豆精品传媒|
国产00粉嫩馒头一线天20p|
精品无码久久久久久国产|
日韩一级电影在线|
91欧美日韩在线一区|
99久久精品国内|
国产成人一区二区三中文|
精品久久久久久国产免费|
国内熟女精品熟女A片视频小说|
最近中文字幕视频2019年|
男生女生一起愁愁愁很痛|
97人妻人人做人人爱|
粉嫩av一区二区白浆|
色欲久久精品AV无码|
亚洲韩国偷拍在线观看|
大陆色情免费视频观看|
福利姬国产精品一区在线观看|
久久久精品国产SM最大网站
|
日本精品巨爆乳无码大乳巨H|
欧洲 亚洲 国产图片综合|
亚洲中文字幕无码专区日本苍井空|
亚洲欧美中文无码蝴蝶|
秋霞成人无码免费A片|
中文字幕一区二区视频|
日本无码人妻一区二区免费不卡|
日本又色又爽又黄的A片视频免费|
掀开奶罩边吃边摸娇喘H片|
亚洲AV久久久噜噜噜久久|
精品日韩二区三区精品视频|
人妻精品人妻无码一区二区三区|
欧美性videodessxo|
在线精品免费视频中文字幕
|
少妇搡bbbb搡bbb搡太痒|
欧美午夜精品一区二区蜜桃|
乱亲女洗澡69XX|
国产丝袜视频一区二区三区|
一边吃胸边膜下免费版刺激|
精品www久久久久久奶水|
欧美又粗又大又爽又色A片|
色一情一乱一乱一区99AV|
最新偷窥盗摄视频在线|
激情婷婷丁香五月色综合|
强奸日本大奶子片一区二区|
国产精品一区二区在线播放|
国产精品久久久久久高潮|
久久这里的只有是精品23|
伊人亚洲AV久久无码精品|
深爱婷婷国产在线精品AV|
亚洲性爱视频免费看|
日产黄片中文字幕|
国产一区日韩一区二区三区|
全黄做爰100分钟视频|
玩弄放荡人妻一区二区三区|
国产超碰人人爽人人做人人添|
成人无码区免费A片视频WWW|
国产精品人妻久久AI换脸|
早上躁晚上躁天天躁8090|
男人撕开奶罩揉吮奶头GIF|
最近中文字幕MV免费视频|
国情侣偷拍视频在线看出租屋|
国产又污又爽又黄又刺激网站|
老湿机免费体检三分钟十八岁|
日韩做A爰片久久毛片A片毛茸茸|
内射老妇女BBWXOCLOCK|
中文字幕亚洲中文精品乱码在线
|
亚洲AV无码乱码在线观看代蜜桃|
44西西人体做爰大胆视频|
2019一本大道香蕉大在线|
精品AV亚洲一区二区|
成人性情视频在线免费观看|
高潮精品视频国产|
18csgo.cn|
免费永久观看美女视频网站网址|
www.射.com|
国产超碰人人爽人人做人人添
|
偷拍精品视频一区二区三区|
成人做爰免费A片视频二机片|
久久精品无码欧美成人一区|
少妇被又大又粗下爽A片|
丁香婷婷五月情天|
91蜜汁在线一区二区三区|
91中文日韩欧美 |
欧洲亚洲精品A片久久99果冻|
日韩中文字幕色网视频|
把舌头伸进去添我的批真舒服视频|
777色情在线无码|
成年视频网站在线观看777|
久久精品国产亚洲A无码|
成人免费的性色视频网站|
丰满女邻居的嫩苞张开|
无码人妻精品一区二区蜜桃色|
久艹视频在线免费观看|
春色校园人妻综合|
被黑人强到高潮喷水A片|
成都视频高清完整版在线观看|
久久人妻无码毛片A片涩天使|
国产传媒18精品A片在线观看|
亚洲色无码A片一区二区情欲|
国产日韩欧美视频免费观看一区二区三区|
欧洲色情三级欧美三级视频|
成人在无码AV在线观看一|
中国孕妇XXXXXXXXX孕交|
女女AAAA视频在线观看|
99亚洲精品色情无码久久|
久久99热人妻偷产国产|
免费黄色福利网站网址|
日日摸夜夜添夜夜添高潮免费A片
亚洲va在线va天堂va手机
|
北条麻妃高清无码中文|
国产无套内射久久久国产|
久久AV无码乱码A片无码|
91人人妻澡人人爽人人精品|
性做爰A片免费视频A片直播|
少妇寂寞被按摩师|
榴莲视频下载APP|
欧美阿v不卡资源在线|
免费看少妇高潮A片黄|
aⅴ免费一区二区三区|
亚洲精品久久7777777|
一本道道中文无码无卡|
2024AV天堂手机在线观看|
啊轻点灬公大JI巴又大又|
日韩一级电影在线|
国产色情A久久无码影|
91人人妻澡人人爽人人精品|
国产又粗又猛又爽又黄的小说软件
|
熟女一区二区三区免费|
99久久精品免费看国产免费粉嫩|
我和丰满老师疯狂做爰在线观看|
又黄又无遮挡又湿的视频网站|
免费的黄网站网址大全|
三男挺进一女爽爽爽小说|
国产SUV精品一区二区88L|
日本VA在线视频播放|
2023无人区码一码二码三码|
一个人看片视频www|
无码人妻精品一区二区三区蜜臀|
精品综合久久久久久97|
嫩模写真一区二区三区三州|
精品手机在线1卡二卡3卡四卡|
九九久久免费视频|
草莓网站在线观看|
娇喘潮喷抽搐高潮麻豆A片|
亚洲区色情区激情区小说纯熟调抖|
成人好吊妞在线播放|
成人情趣久久天堂日韩|
欧美无人区卡1卡2卡3|
91精品国产观看免费观看
|
龙欲h粗喘强占公妇H|
欧美狂操一区二区三区|
成人国产一区二区精品小说|
5av国产精品爽爽ⅴa在线观看|
91免费永久国产在线观看|
白白操福利视频免费观看|
麻豆视传媒短视频的服务行业|
久久午夜无码鲁丝片午夜精品|
亚洲中文字幕婷婷在线|
中文字幕黄色av首页网站|
小明看看wwwxXX.2015|
色片段高清在线观看|
国产午夜亚洲精品理论片八戒
|
亚洲AV无码乱码国产麻豆穿越|
成全久久免费高清大全AV|
午夜精品久久久久久久无码软件|
99re热视频在线|
www嫩草com|
99久久国产热无码精品免费 |
老少欢另类日本xxx|
日韩一卡2卡三卡4卡无卡网站
|
99精品众筹模特私拍|
2019日韩中文字幕MV|
国产又色又爽又黄的男女小说免费|
欧洲老妇60一70|
免费观看成人毛片A片2008|
av天堂久久天堂av|
国产Av影片麻豆精品传媒|
免费阿v网站在线观看g|
男人J桶进女人下部无遮挡A片|
内射老妇女BBWXOCLOCK|
国产真实乱人偷精品人妻69|
2019最新福利天堂视频92视频|
麻豆国产人妻欲求不满谁演的|
真人一进一出抽搐无遮挡|
少妇人妻偷人精品无码91动漫|
欧美特级特黄AAAAA片|
精品一区二区三区在线成人|
成人自拍视频在线观看|
亚洲不卡在线观看|
cijilu在线视频|
亚洲中文无码永久免费|
成人在无码AV在线观看一|
国产成人av在线影院 |
亚洲欧美婷婷五月色综合麻豆
|
丁香婷婷五月情天|
亚洲一区二区三区四区五区六|
女人扒开屁股桶爽30分钟|
蜜桃日本免费看MV免费版|
日日摸夜夜添夜夜添A片牛牛影视|
亚洲.日韩.欧美另类
|
少妇高潮免费看一级A片精东影视|
亚洲AV无码区在线观看东京热|
无码精品人妻一区二区湖北九色|
黄污色污国产高清无码在线观看|
日韩色情无码免费A片|
久久99爱re热6在线播放
|
少妇被下春药玩弄A片|
播放真实国产乱子伦视频|
色欲狠狠躁天天躁无码中文字幕|
国产人妻人伦精品1国产盗摄|
jizzjizzjizz亚洲熟妇|
亚洲AV久久无码精品热九九|
www一区二区三区中文字幕|
国产激情黄A片无遮挡|
国产成人无码性教育视频
|
无码性午夜视频在线观看|
草草视频网站在线观看|
丰满爆乳中文字幕亚洲人妻有码在线|
免费人成在线观看网站品爱网|
久久无码一区二区三区少妇|
91无码精品人妻一区二区|
欧美一区二区三区性视频|
aa电影无码国产|
国产亚洲精品久久久久久久久动漫
|
日韩一区二区三区视频在线观看
|
国产成人a在观看网站国产成人|
午夜dj在线观看免费完整高清神马|
在线观看成人A片免费播放|
国产亚洲精品久久久久久无码网站
|
日本一道人妻无码一区视频|
国产老熟女伦老熟女熟妇图片|
国产一级性爱视频|
成年美女黄网站色大免费全看|
中国的黄片1级片看一下视频|
欧美の无码国产の无码影院|
亚洲国产精品无码久久一区二区
|
色欲人妻无码AV专区|
中文字幕黄色av首页网站|
亚洲精品久久久久久久久久飞鱼|
亚洲视频在线观看一区|
最近中文字幕MV国语免费下载
|
久久久www免费人成黑人精品|
日本黑人人妻一区二区水多多|
欧美日韩一级特大黄片|
亚洲 自拍 欧美 小说 综合|
无码人妻丰满熟妇啪啪欧美|
最近2019手机中文字幕下载|
99久久久久久亚洲精品|
av噜噜久久精品|
女人囗交吞精口视频|
又黄又大又猛的A片|
日韩18视频在线观看|
亚洲成A人片在线播放器|
国产亚洲麻豆精品AA片在线观看|
成人黄网站A片免费观看|
99久久精品免费看国产免费粉嫩|
最近免费2019中文字幕大全
|
十八禁无码啪啪无遮挡网站
|
久久夜色精品国产噜噜A中文|
http www.you jizz|
亚洲精品久久久久中文字幕二区|
国产色欲AV亚洲三区天美传媒|
久久久久久国产精品超碰|
1区2区3区4区产品不卡码|
老师我好爽再深一点动态图
|
成人免费的性色视频网站|
1024欧美日韩熟妇人妻|
欧美の无码国产の无码影院|
精品无码久久久久久国产牛牛影视|
噜噜噜狠狠夜夜躁精品仙踪林|
国产精品悠悠久久人妻精品|
女女AAAA视频在线观看|
午夜亚洲人成网站|
18禁美女黄网站色大片免费看|
丰满人妻妇伦又伦精品国产|
1区2区3区4区产品不卡码|
婷婷综合另类小说色区|
国产精品成人va在线观看网|
成人国产一区二区精品小说|
无码中文字幕波多野结衣|
国产亚洲精品久久久久久久久动漫|
一本大道高清香蕉中文大在线|
皇色在线国内外视频|
久久免费看少妇高潮A片麻豆|
调教超级YIN荡玩物学生H|
99久久精品无码专区免费|
亚洲一区二区三区四区五区六|
极品少妇伦理一区二区|
漂亮人妻被公日日躁国产|
精品无人无码乱码毛片国产小说|
www.一区二区|
成人网站偷拍澡AAAA|
日日摸夜夜添夜夜添A片看见
|
亚洲男女羞羞无遮挡久久丫|
亚洲欧美婷婷五月色综合麻豆|
51久久成人国产精品麻豆|
欧美性A片又大又长|
波多野结av衣东京热无码专区|
男人吃奶摸下边特黄A片|
国产午精品午夜福利757视频播放
麻豆果冻传媒在线观看
|
国产99视频在线观看|
曰本一本道a东京热播|
国产女13黄A片AAA片视频|
成人片黄网站A片免费|
日日摸天天碰中文字幕|
欧美国产一区二区不卡|
一本av高清一区二区三区|
av免费黄色在线|
国产福利美女福利视频免费看|
国产18禁黄网站免费观看|
A片扒开双腿猛进入免费观
|
邻居少妇被爽到高潮A片|
麻豆精品传媒一二三区|
国产人妻系列无码专区第二页|
精品久久久久久久无码伊人|
日韩福利午夜无码免费|
边啃奶头边躁狠狠躁A片动漫
|
精品国产三级大全在线观看|
久久这里只精品99百度|
男人和女人一级黄色大片|
人妻性奴波多野结衣无码|
欧美日韩久久久精品A片|
最近中文字幕MV在线2018|
欧美+日本+国产高清|
越南女子杂交内射BBWBBW|
寡妇张开腿让黑人捅爽|
思思久久99热只有频精品66|
2020国产成人精品视频 |
国产麻花豆剧传媒精品MV在线|
国产综合无码一区二区色蜜蜜|
欧美日韩中文在线播放专区|
老熟女强人国产在线视频|
人妻av无专码专区久久|
亚洲国产片免费在线观看|
91欧美激情免费一区二区|
国产人妻XXXX精品HD|
A片无码午夜久久久涩涩|
成年免费大片黄在线观看免费|
精品无人区卡一卡二卡三|
国产69精品久久久久人妻|
国产又污又爽又黄又刺激网站|
公交车上疯狂做爰高潮av|
久久免费看少妇高潮A片手机版|
japanese在线播放国产|
成人国产精品日本在线|
四虎8848a成人亚洲五品|
久99久热只有精品国产99|
se01短视频国产在线|
黑人巨大两根一起挤进A片视频|
国产熟妇久久精品亚洲熟女图片|
乱码精品一卡2卡二卡三|
chinese熟女熟妇m1f|
亚洲国产一卡2卡3卡4卡5公司|
男人和女人一级黄色大片|
日本道免费精品一区二区|
欧美成人精品一区二区综合A片
|
欧美一级aaaaA久久久|
欧美日韩中文字幕一区二区高清|
伊人22综合网图片|
内射爽无广熟女亚洲|
福利姬国产精品一区在线观看|
AV久久无码AV喷水高潮|
国产亚洲精品久久久久久久久动漫|
公车上双乳被老汉揉搓玩弄漫画|
国产精品一级黄色在线播放|
亚洲精品91一区二区三区
|
亚洲综合在线另类色区奇米97
|
国产欧洲野花A级|
污软件在线观看软件|
中文字幕在线不卡视频蜜乳|
亚洲精品久久久久久久久久飞鱼
|
美女又爽又黄视频|
国产精一品亚洲二区在线播放|
蜜臀AV色欲A片无人一区|
九九精品视频在线插放|
麻豆果冻传媒一卡二卡|
XXXxA特别高潮|
国产尤物电影在线观看网站免费|
强插女教师AV在线|
国产熟妇的荡欲午夜视频|
韩国一级黄色毛片|
国产毛片女人高潮叫声|
青青草原精品国产亚洲AV|
男人J桶进女人下部无遮挡A片
|
日日夜夜精品视频|
91久久香蕉青青草原娱乐 |
超爽超碰人人做wwwcom国产|
波多野结衣AV无码久久一区|
成人麻豆日韩在无码视频|
夫の前で痴汉に绝顶人妻国产剧|
女人扒开下面无遮挡|
91亚洲精品五月天|
天堂MV在线MV免费MV香蕉|
国产呦交精品免费视频|
国产精选莉莉私人影院|
99热在这里只有免费精品|
成人精品视频99在线观看免费|
国产精品人妻一码二码尿失禁|
日本一本道无码a在线|
19不插片免费视频|
欧美成人精品动漫在线专区|
2021久久精品免费观看|
久久久国产人妻精品|
国产丰满大屁股大乳A片动漫|
亚洲欧美中文无码蝴蝶|
久久国产人妻一区二区免色戒电影|
欧美巨大巨粗XXXOOO|
人妻精品人妻无码一区二区三区|
吉根柚莉爱在线乱码亚洲|
国情侣偷拍视频在线看出租屋|
秘书下面太紧拔不出来怎么办|
12一14性xxxxx国外|
亚洲精品乱码8久久久久久日本|
WWW国产亚洲精品久久麻豆|
麻豆果冻传媒在线观看|
sebowuyuetian|
麻豆精东九一传媒在线观看|
亚洲精品久久久鸭子|
欧美自拍嘿咻内射在线观看|
久久夜色精品国产欧美乱极品|
亚洲aⅴ无码专区在线观看q|
强开乳罩摸双乳吃奶视频|
日韩欧美群交P片內射中文|
日韩一级视频在线观看播放|
暴力糟蹋人妻HD中文字幕免费
|
无码又爽又刺激视频A片涩涩|
AV无码国产精品午夜A片麻豆|
超碰无码精品一区二区三区|
亚洲欧美色国产综合|
2020最新中文字幕在线|
无码性午夜视频在线观看|
亚州一级毛片在线|
国产乱码精品一区二区三区四川|
亚洲老司机成人精品影院|
试看免看一级a一片
|
免费人成在线观看网站品爱网|
中文字幕一区二区在线观看|
亚洲aⅴ无码专区在线观看q|
麻豆国产精品AV色拍综合|
A级A片A少妇高潮|
乱亲女洗澡69XX|
E91麻豆国产福利精品|
国产人妖在线另类专区|
成人嫩草国产精品|
精品久久久久中文字幕一区|
亚洲视频在线观看网站
|
99在线精品视频在线观看3|
亚洲欧美日韩在线观看一区二区三区
|
91精品日韩欧美国产|
亚洲AV久久无码精品九九软件|
乱码一区入口一欧美
|
国产精品久久久久久喷浆|
无码专区文字幕无码野外|
免费观看黄色a一级视频播放
|
中文字幕aⅴ一区二区三|
久久久久成亚洲综合精品|
惠民福利亚洲人成电影福利在线播放|
又湿又深又爽的A片视频|
亚洲色欲色欲WWW在线丝|
熟妇的荡欲色综合亚洲图片|
免费的黄网站网址大全|
精品一卡二卡三卡四卡|
国产精品一区二区AV97|
日韩亚洲欧美三级片免费看廣大網友最新影片
|
国产成人AV在线播放影院|
亚洲精品一区二区绿巨人|
久久精品视频在线直播6|
午夜亚洲福利在线老司机|
亚洲日韩大佬色蜜桃91|
高潮毛片又色又爽免费|
日韩人妻无码精品A片免费不卡|
高潮迭起AV乳颜射后入|
成年女人免费播放影院|
国产成人AV激情在线播放|
成人 亚洲一区二区|
好硬好紧A片视频免费看|
伊人影院蕉久影院直播福利|
国产福利小视频尤物98|
国产伦精品一区二区免费|
搡女人真爽免费视频网站|
视色在线观看网站|
日韩特黄特色大片免费视频|
国产午夜精品一区二区三区嫩草|
亚洲日韩精品AV成人波多野结衣|
我和丰满老师疯狂做爰在线观看
|
韩国无码色情在线播放|
日韩精品一区二区无码|
欧美的又大又长做禁片A片|
涩涩日韩黄色无码一区二区三|
国产SUV精品一区二妻|
被老外添嫩苞添高潮NP|
在线看免费无码A片视频|
小明看看2017永久网站|
2019一本大道香蕉大在线|
99久久国产综合亚洲区|
91亚洲精品五月天|
亚洲av成人免费在线观看|
亚洲无人区码一码二码三码区别|
搡BBBB槡BBBB|
青青草原亚洲精品在线观看
|
日韩在线观看精品|
日本后妈色情动画片|
久久久久99999热只有精品|
国产欧美精品AAAAAA片|
日本调教虐乳在线观看|
91在线欧美日韩精品|
H狠狠躁死你H各种姿势|
亚洲精品乱码一区二区三区
|
国产-第1页-草草影院|
伊人亚洲AV久久无码精品|
久久国产精品激情对白|
91无码精品人妻一区二区|
久久强奷乱码老熟女|
亚洲欧美一区二区三区九九九|
日韩精品一卡2卡3卡4卡新区|
快插我BB好爽舔我视频|
不卡高清中文字幕在线播放|
亚洲精品九色在线网站|
亚洲国产精品成人a|
涩涩日韩黄色无码一区二区三|
国产乱码免费卡1卡二卡3卡四卡|
韩国精品无码少妇在线观看网站|
桃谷绘里香初尝黑人巨炮网址|
91黄色在线观看 |
国产乱码卡二卡三卡老狼在线观看|
女人18毛毛片兔费码A片|
多毛熟女HDVido多毛的简介|
国产精品美女在线看片|
婷婷激情五月AV在线观看|
高清一卡二卡三卡四卡免费观在线|
欧美做爰片高潮视频|
日本无码蜜桃波多野结衣|
欧美综合在线网不卡|
黄色片色狼片爽爽爽|
99精品热在线观看色网手机版|
久久久久久久久久久免费精品国产|
精品区2区3区4区产品乱码9|
成年女人免费视频播放7777|
男人的天堂在线视频|
国产无码一二三专区|
性色AV一区二区三区咪爱四虎|
7777精品伊人久久久大香|
91精品免费久久久久久久久|
亚洲男人的天堂A片我要看|
亚洲v欧美v日韩v国产v91|
亚洲精品一区三区三区在线观看|
国产人妻无码鲁丝片久久麻豆
|
亚洲午夜精品A片久久W|
久久第一时间观看国产卡顿
|
国产亚洲精品久久精品69|
免费国产成人高清在线网站东京|
丰满人妻老熟妇伦人精品|
少妇做爰特黄A片免费看|
WWW.一本色道88久久爱|
亚洲自偷自偷在线制服|
艳妇臀荡乳欲伦交换AV1|
骚虎成人免费99XX|
男男做爰猛烈高潮在线观看|
91亚洲欧美日产综合在线网|
果冻传媒色AV国产播放|
特级毛片在线大全免费播放|
免费看高视频hh网站免费|
国产浓毛大泬熟妇视频
|
精品无人区卡卡二卡三乱码|
97人摸人人澡人人人超一碰|
白嫩少妇激情无码|
国产精品583一区二区免费看|
乱码午夜-极品国产内射|
欧美精品1区2区3区|
中文日产无乱码AV在线凹凸|
国产成人精品一区二区免费
|
国产一级av毛片|
国产熟妇搡BBBB搡BBBB|
超薄肉色丝袜一二三四区|
日本一卡二卡三卡四卡免费网站|
51久久国产露脸精品国产|
韩国无码又爽又刺激的A片|
蜜桃一区二区在线视频|
99久久中文字幕伊人|
亚洲国产另类久久久精品黑人
|
精品无码人妻一区二区三区色|
激情欧美性AAAAA片|
精品国产三级?V无码|
国产a国产片国产|
亚洲AⅤ无码日韩AV中文AV伦|
麻豆国产精品AV色拍综合|
成人免费看A片WWW|
女人扒开屁股桶爽30分钟|
国产av巨作情欲放纵无码下载|
欧美性狂猛AAAAAA|
AV国产天美传媒性色AV|
亚洲成人综合中文伊人|
白白嫩嫩BBWBBWDI|
国产成人精品日本亚洲11|
疯狂揉吮少妇嫩草99AV小说|
国产卡一卡二无线乱码|
国产日产欧产精品精品APP|
久久精品女人天堂|
日韩精品极品视频在线观看免费
|
成人午夜伦理福利电影|
亚洲精品久久久久久AV|
男人边吻奶边挵进去A片无码免|
蜜臀av性久久久久蜜臀aⅴ流畅
|
三级男人添奶爽爽爽视频|
亚洲精品AV无码精品|
黄网站涩免费蜜桃网站|
不充会员的爽爽影院|
avtt天堂东京热一道本|
欧美成人免费做真爱A片|
黄色网址A片XXX日本|
久久婷婷五月综合色情|
好看的国产精彩视频|
成人区精品一区二区婷婷|
国产乱人乱偷精品|
国产精品久久久久久99人妻绯闻|
人妻无码一二三区|
大叫受不了了好爽国产在线|
亲胸揉胸膜下刺激娇喘免费视频|
欧美大屁股熟妇BBBXXX|
色狠狠躁日日躁夜夜躁A片55|
好男人在线视频神马影视WWW|
国产卡二卡三卡四乱码分类|
三级成人AV电影在线观看|
亚洲A片无码秘色多多|
国产又色又爽又刺激在线观看|
丰满熟妇啪啪区日韩久久|
一道本免费高清中字幕1V1|
久久久精品理论A级A片|
添女人荫蒂全部过程AV|
顶级欧美做受xxx000大乳|
色婷婷久綜合久久一本國產AV|
中文字幕人妻熟女人妻|
无码专区久久综合久综合字幕|
超碰久久国产av|
成人无码区免费A片视频日本|
99国产精品免费视频观看|
少妇水又多又黑又长A片动漫
|
大香伊蕉在人线国产手机看片|
2022国内精品免费福利视频|
kaixinbobowang|
国产一卡2卡三卡4卡免费网站|
日本午夜精品理论片A级APP发布|
亚洲欧美中文字幕高清在线|
午夜精品视频一区二区在线观看|
一边喂奶一边挨CAO|
韩国青草视频19禁福利|
捧着莹莹的腿疯狂输出视频
|
国产AV高清怡春院|
美女诱惑亚洲一区|
精品国产一卡2卡3卡4卡新区
|
精品久久久久久久无码伊人|
gogo人体美鮑|
免费的两性视频网站|
99RE久久爱五月天婷婷|
91人妻中文字幕无码专区蜜一精品
|
一区一区三区四区产品动漫|
成年人短视频在线观看网站|
欧美激情A片无码大尺|
国产群交轮流内射骚|
麻豆短视频app官方|
国产探花在线精品一区二区|
很黄又污又色情又爽又猛|
波多野结衣紧身裙女教师|
国产日韩欧美视频免费观看一区二区三区
|
日韩精品无码一区二区三区电影院
|
9国产露脸精品国产麻豆|
国产91久久无码精品亚洲日韩|
国产精品自在自线亚洲|
乱码中字芒果视频一二三多人
|
国产三级黄色免费|
日本一卡二卡三卡四卡免费网站|
岛国美女全棵写真视频在线观看|
无码日韩精品快射视频|
欧美+日本+国产高清|
自拍偷拍午夜福利|
欧美3p两根一起进高清视频|
伊人久久大香线蕉综合99|
久久久视频2019午夜福利|
99国产中文字幕|
亚洲精品国产自在久久出水|
国产人妻人伦精品9|
少妇人妻偷人精品无码视频新浪|
亚洲欧美色国产综合|
好硬好紧A片视频免费看|
99xxxx.com|
亚洲国产精品成人a|
人妻饥渴偷公乱中文字幕|
亚洲国产精品福利在线无卡一|
轻轻一摸就出水13p|
少妇饥渴偷公乱AV在线观看涩爱|
国产一区二区无码精品小说|
91国产自产精品a|
摸添揉捏胸还添下面视频|
风韵丰满熟妇啪啪区老老熟女百度|
成人午夜福利电影天堂|
欧美黑人一区二区三区免费A片|
亚洲av乱码久久观看|
丰满少妇被猛烈进AV毛片|
内射老妇女BBWXOCLOCK|
www.日本视频在线观看|
六月丁香久久婷婷色综合|
亚洲精品卡一卡二卡3卡乱码|
亚洲AV久久无码精品热九九|
国产一二三精品无码不卡日本|
97色伦婷婷综合色情网|
精品国产三级?V无码|
国产精品日本不卡一区二区|
国产丰满老熟妇乱XXX1区|
歪歪爽蜜臀AV久久精品人人槡
|
亚洲国产色情在线观看|
免费100款禁用黄台网站|
丁香婷婷色五月激情综合|
色翁荡熄系列白洁2|
日本不卡免费视频新二区|
久久久久99999热只有精品|
久久精品亚洲精品一区|
两性午夜刺激爽爽视频|
高清一卡二卡三卡四卡免费观在线|
蜜臀亚洲AV永久无码精品老司机|
国产乱码精品一区二区三区四川|
日产区一线二线三线A7778|
国产亚洲精品A片久久久|
日韩一区二区三区无码|
国产黄色视频黄色视频|
欧美叉叉叉BBB网站|
老牛无码人妻精品1国产|
亚洲国产成在线网站91|
97色伦午夜国产亚洲精品|
JIZZZJIZZJI大|
4四虎影库永久在线|
亚洲精品乱码一区二区三区|
精品国产sm在线大全|
国产熟妇精品伦一区二区三区
|
一区二区人妻精品无码A片|
忘忧视频在线观看免费播放|
国产喷水1区2区3区咪咪爱AV|
成人国产精品日本在线|
亚洲 第一区 欧美 日韩|
精品麻豆一卡2卡三卡4卡乱码|
国产成人MV毛毛A片小说|
又大又紧18P少妇在线观看|
又硬又粗进去爽A片免费无码|
无码欧美喷潮福利XXXX|
国产精品99久久久久久久女警
|
蜜臀av性久久久久蜜臀aⅴ流畅|
av色国产精品喷浆|
惠民福利无码少妇精品一区二区免费动态
|
日韩午夜资源在线|
国产亚洲精品久久精品录音|
丁香六月婷婷七月激情|
亚洲AV综合AV国产AV|
亚洲日韩国产精品乱|
日韩美女自卫慰黄网站|
(乱子伦)国产精品|
性一交一乱一能一八一片|
国产揉捏爆乳巨胸挤奶视频|
国内精久久久久久久久久人|
国产麻花豆剧传媒精品MV在线|
WW含羞草传媒在线观看|
春色校园人妻综合|
色情成人吃奶激情视频在线播放|
一级特黄特色的免费大片视频
|
亚洲精品第一区二区APP|
WWW国产亚洲精品久久麻豆|
四十如虎的丰满熟妇啪啪|
高清无码视频在线播放|
新超碰97在线观人人澡|
欧美一区二区三区性视频|
brazzers欧美精品|
精品一区精品二区|
精品无码人妻一区二区三区视频|
WWW.一本色道88久久爱|
CAO死你好紧好爽好湿视频男男|
CHINA东北女人对话过瘾|
美女视频黄a视频全免费网站色窝|
成在人线av无码A片试看|
51久久成人国产精品麻豆|
69国产精品人妻无码免费 |
午夜福利1000集无码|
好爽好深好猛好舒服视频上|
成人久久18秘免费网站|
亚洲日韩人妻在线图片视频|
福利姬国产精品一区在线观看|
亚洲欧美一区二区久久|
亚洲AV久久无码精品九九小说|
色婷婷wAV秘 一区二区|
日日碰狠狠躁久久躁77777|
又大又爽又黄无码A片在线观看
|
伊人2019视频免费观看|
日韩一区二区三区视频在线观看|
曰本一道本久久88不卡|
秋霞成人无码免费A片|
日韩一卡2卡三卡4卡2022精品|
精品人妻少妇一区二区三区在线|
国产精品久久久久无毒|
爽爽影院免费观看视频|
99久久久无码国产精品免费蜜柚|
丁香花五月天婷婷夜色|
2021国产最新盗摄在线播放|
国产剧情一卡二卡麻豆|
欧洲一卡2卡3卡4卡免费观看|
国内精品乱码卡一卡2卡|
激情欲成人AV在线观看AV性|
亚洲色欲色欲77777小说|
日韩精品无码一区二区免费A片|
五月婷婷开心中文字幕|
91肉色超薄丝袜脚交一区二区
|
国产激情一区二区三区无码|
67pao成人国产永久免费|
波多野结衣在线观看免费区|
亚洲韩国偷拍在线观看|
日本无码一二三区别免费|
啊灬啊灬啊灬快灬喷水了|
欧美毛片又大又粗无码电影|
丰满少妇猛烈进入A片99A|
精品国产露脸久久AV麻豆
|
大战熟女丰满人妻AV|
国产人妻人伦又粗又大爽电影|
日小骚B少妇真舒服|
国产凹凸一区在线观看视频|
成人片黄网站A片免费|
青青视频 在线 在线播放|
开心片色99xxxx|
青柠社区在线观看免费完整版|
欧美一级黄色日韩|
欧美精品久久99人妻无码|
忘忧视频在线观看免费播放|
综合欧美一区二区三区|
久久久久99999热只有精品|
亚洲精品一区二区绿巨人|
免费看成人A片无码网站|
大战熟女丰满人妻AV|
大波熟女熟妇30p|
玩弄放荡人妻一区二区三区|
一道本视频一二三区|
欧美高清milf在线播放|
亚洲av成人无码无在线观看|
亚洲精品久久一区二区三区777
|
国产成人av一区二区三区无码|
亚洲欧美成人高清在线|
丰满少妇被猛烈进AV毛片|
日日夜夜精品视频|
日本中文字幕乱码免费|
久草在视频免费福利|
91精品国产免费久久久久久青草|
香蕉国产精视频在线观看|
搡女人真爽免费视频网站|
午夜成年奭片免费观看|
欧美 亚洲 日韩 中文2019|
成人精品免费av不卡在线观看|
亚洲乱码一卡二卡四卡乱码新区|
欧美特级特黄AAAAA片|
人妻少妇偷人精品无码|
午夜理论日本乱人伦片中文|
欧美又硬又粗进去好爽A片|
国产精品无码久久蜜臀av|
熟年夫妇の密着浓厚交尾|
久久人人槡人妻人人玩夜色AV|
国产成人精品一区二三区在线观看|
亚洲欧美日韩在线观看一区二区三区|
真实国内老女人的露脸视频|
91精品免费久久久久久久久|
精品国产无码日韩一三区|
欧美又硬又粗进去好爽A片|
最近最好的2019中文|
中文字幕2018年最新中字版|
极品吹潮视频大喷潮tv|
女bbbbxxxx另类亚洲|
边做边爱完整版免费视频播放视频
|
男人的天堂在线视频|
免费无码又黄又爽又刺激|
中字幕久久久人妻熟女天美传媒|
国产狂喷水潮免费网站www|
依人在线久在线视频|
国产精品色情国产三级在线观|
大荫蒂又大又长又硬又紧又粗|
内射精品无码中文字幕|
中文字幕在线永久播放|
欧美S码亚洲码精品M码|
黄污色污国产高清无码在线观看|
99re国产美女在线|
欧美+日本+国产高清|
在线观看的a站 最新|
国产一区亚洲专区|
国产成人久久综合一区日韩在线观看|
国产三级精品三级在线观看|
嗯灬啊灬把腿张开灬A片MBA|
美女诱惑亚洲一区|
av在线一区二区中文字幕
|
一卡二卡三卡四卡无卡免费播放在线观看|
日韩欧美口爆有吗在线|
粉嫩虎白女流水白浆在线播放|
AV天堂久久天堂色综合 |
麻豆国产96在线日韩麻豆|
av噜噜久久精品|
亚洲欧美在线观看|
青花电影在线观看免费|
国产日韩欧美视频免费观看一区二区三区
|
WWW日韩AV免费高清看|
亚洲国产片免费在线观看|
波多野办公室激情A片|
手机在线亚洲国产精品|
国产日韩欧美高清免费视频|
国产女教师一级爽A片|
99精品众筹模特私拍|
浪潮AV色综合久久天堂|
成人黄色免费网站在线|
免费国产成人高清在线网站东京|
最近中文字幕视频2019年|
成人啪啪高潮不断观看|
67pao成人国产永久免费|
91偷拍免费在线观看视频|
男女免费观看高清啪啪P水
|
日本无吗无卡v清免费网站|
插桶30分钟一卡二卡三卡四卡|
欧美又大又粗又湿A片|
亚洲熟妇AV影院|
在教室伦流澡到高潮HGL动漫|
国产精品jizz在线观看软件
|
91免费精品国自产拍在线可以看|
国产艳妇AV在线观看果冻传媒|
国产无套内射久久久国产|
激情综合丁香婷婷色五月|
国产揉捏爆乳巨胸挤奶视频|
五月色丁香婷婷网蜜臀AV|
色欲AV蜜臀AV在线观看麻豆|
一本大道视频大全在线|
一本一道人妻久久久久久中文字幕|
无套内谢的新婚少妇国语播放|
噜噜AV亚洲一区二区|
亚洲精品久久无码AV片麻豆|
北条麻妃jul一773在线看|
国产精品乱码久久久久久软件|
www.久久精品视频|
日本花心黑人hd捆绑|
亚洲精品美女av在线|
人人妻人人澡人人爽人人DⅤD|
亚洲99精品A片久久久久久|
欧美 亚洲 日韩 中文2019|
狠狠的撸2016最新版
|
成人国产精品影院|
国产午夜免费视频片夜色|
姑娘3完整版《在线观看》|
国产日韩免费无码一区二区|
九九综合VA免费看|
亚洲 动漫 偷拍 另类 校园|
色欲人妻无码AV专区|
强伦轩人妻一区二区三区70后
|
乱伦日本亚洲中文|
国产50岁熟妇露脸|
国产亚洲精品久久久久久无码网站
|
国产乱色国产精品免费|
午夜福利杨幂在线视频|
996这里只有精品|
国产精品视频一区二区三区|
日本中文字幕乱码免费|
最新亚洲精品成人在线|
国产精品乱码色情一区二区视频
|
朋友人妻翘臀迎接我粗大撞击|
222com奇米第四色|
又黄又爽又无遮挡在线观看免费|
亚洲精品国产SUV|
日本黑人乱偷人妻中文字幕|
97精品国自产在线偷拍|
少妇性BBB搡BBB爽爽爽小说|
色欲久久精品AV无码|
91兰州熟女富婆露脸|
黑人狂躁中国人的A片刘玥|
丰满少妇高潮惨叫在线观看|
三级男人添奶爽爽爽视频|
男人大JI巴做爰视频D2|
国产精品国产三级国AV在线观看|
狠狠躁日日躁夜夜躁A片|
美女被C到爽哭视频网站|
人妻中文字幕aⅤ精品视频|
亚洲熟女片嫩草影院|
放课后の优等生 3熟肉|
一本大道一卡二卡免费|
亚洲国产精品无码久久一区二区|
久久第一时间观看国产卡顿|
老大太bbwbbwbbw|
老师我好爽再深一点动态图|
精品国产99久久久久久宅男|
成人做爰视频WWW网站|
2021乱码精品1区2区3区|
免费看男女下面日出水视频|
中文字幕理伦午夜福利片|
A片扒开双腿猛进入免费|
日产乱码卡一卡2卡三卡四福利
|
国产精品无码久久蜜臀av|
青青草视频在线观看免费|
大陆久久久久久久免费视频|
夫目前犯人妻av中文字幕|
狠狠爱亚洲五月婷婷av|
女bbbbxxxx另类亚洲|
四虎影视8848aamm在线观看|
爽爽影院免费观看视频|
成人电影偷拍自r拍|
精品网址你懂的在线观看|
高清在线不卡国产|
欧美巨大性欧美精品粗大猛烈|
1024免费看片|
欧洲精品不卡1卡2卡三卡四卡|
五月婷婷丁香花综合网|
老头边吃奶边弄进去呻吟|
四川揉BBB搡BBB|
91人妻岛国视频免费看|
国语熟妇乱人乱A片|
色狠狠躁日日躁夜夜躁A片55|
HEYZO中文字幕无码|
最近更新中文字幕免费完整版|
有人有看片的资源吗WWW在线|
亚洲精品白浆高清久久久久久|
国产特黄级AAAAA片免|
日韩欧美国产免费看清风阁|
小雪被老外性调教1-8|
六月丁香久久婷婷色综合|
国产精品午夜免费福利阅读|
爽爽影院免费观看视频|
日韩中文字幕色网视频|
在线视频免费观看爽爽爽|
日本一本道无码a在线|
女人被添全过程A片免费视频|
欲妇荡岳丰满少妇A片24小时|
亚欧精品一区二区三区四区|
亚洲精品国产综合AV在线观看|
国产啪亚洲欧美精品无码|
影音先锋资源av不撸|
日韩一区二区三区四区区区|
漂亮人妻被公日日躁国产|
亚洲国产综合久久久久|
91妻人人澡人人爽人人精品
|
欧美成人免费VA影院高清|
女女AAAA视频在线观看|
性欧美videoesxxoo在线|
拍拍拍无挡免费视频|
国产亚洲精品久久久999密壂最新版介绍
|
涩涩日韩黄色无码一区二区三|
五月色婷婷亚洲男人的天堂|
成人综合国产在线|
色翁荡熄又大又硬又粗又动态图
|
最新国产精品自产在线观看 |
99r视频国产在线观看免费|
岛国免费视频一区二区|
一级a免费观看完整视频|
成人无码WWW在线看免费|
高清欧美日韩中文字幕 |
欧美无人区码卡1卡2卡免费|
影音先锋av网站大全|
欧美性猛交XXXX乱大交3|
少妇饥渴偷公乱AV在线观看涩爱
|
女人爽得直叫免费视频|
免费番肉动漫在线观看|
国产精品一区二区在线播放|
福利日木AV无码专区亚洲AV毛片|
女同志videos最新另|
91精品国产高清在线观看|
2021韩国理伦电影大全|
曰本一本道a东京热播|
2023无人区码一码二码三码|
午夜67194二线路|
人妻中文字幕aⅤ精品视频|
91在线免费观看不卡|
搡BBBB槡BBBB|
精品日产一卡2卡三卡4卡乱码|
精品人伦一区二区色婷婷|
成人片黄网站A片免费|
精品无码AV在线观看APP|
精品国产露脸久久AV麻豆|
六月丁香久久婷婷色综合|
最近2019中文字幕免费直播
|
冲田杏梨午夜久久99视|
久久久国产精品免费蜜臀|
好紧我太爽了视频免费国产|
97碰碰碰视频在线观看日韩|
五月天色综合图片专区|
国产宾馆偷爱视频在线观看|
国产高清色情在线观看APP|
caoprom超碰公开无码|
机机对机机手机免费下载版大全2022|
色老头永久免费视频|
亚洲无码乱码在线观看|
99视频久九热精品|
亚洲色一色噜一噜噜噜|
日本在线看片免费视频|
2021国产麻豆剧传媒香蕉|
久久这里只精品99百度|
91精品国产观看免费观看
|
日本亚洲精品无码专区国产|
国产亚洲小视频线播放|
五月丁香综合啪啪成人|
99久久99这里只有免费的精品|
亚洲一区二区在线aⅤ|
99在线在线视频观看|
98精品国产综合久|
国产卡一卡二卡3卡四卡精品|
在线观看黄A片免费AV软件|
青色青草热在线网站观看|
欧美巨大性欧美精品粗大猛烈|
国产精品毛片在线完整版SAB等|
色欲AV亚洲午夜精品无码电影|
吃奶呻吟打开双腿做受是免费视频
|
无码色情影片视频在线看免费
|
91大神视频在线播放|
疯狂揉肉蒂高潮H失禁视频|
国产极品JK白丝喷白浆图片|
久久久www免费人成黑人精品|
免费A级毛片在线播放不收费|
日本高清2018字幕|
av综合中文字幕|
日本又黄又爽gif动态图|
又硬又粗进去好爽A片免费多人玩
特黄四级人牲片在线观看
|
国内揄拍国产精品人妻电影|
无码人妻久久一区二区三区蜜桃|
国产在线观看91香蕉|
WWW.一本色道88久久爱|
2021精品1区2区3区芒果 |
亚洲欧美国产高清|
黑人与人妻无码中字视频|
欧美做A视频一区|
卡一卡二卡三在线入口十八岁|
国产AV亚洲精品久久久久久小说|
日韩精品欧美视频|
亚洲字幕AV一区二区三区四区|
亚洲精品夜夜做人人爱|
粉嫩无套白浆第一次jk|
单亲真实乱子伦免费视频|
日韩精品欧美在线视频在线|
3P人妻少妇对白精彩视频 |
色片段高清在线观看|
亚洲 第一区 欧美 日韩|
久久综合给合久久97色|
亚洲精品综合一二三区在线|
欧美高清精品第1页|
久久久久亚洲AV无码AV男人|
91无码精品人妻一区二区|
清除唯美第一区二区三区|
人人爽久久久噜噜噜婷婷|
欧美大屁股熟妇BBBBBB|
丰满少妇猛烈进入A片99A|
亚洲国产精品日韩专区AV|
丰满少妇高潮惨叫在线观看|
性少妇中国内射XXXX狠干|
最猛黑人熟妇性HDXXX|
www.黄av在线免费播放|
免费一级a毛一级a看免费视频下载|
欧美人做人爱A全程免费|
国产午夜精品AV一区二区|
啊灬啊灬啊灬快灬深用力A片|
国产精品V无码A片在线看小说|
综合欧美一区二区三区|
99精产国品一二三产品香蕉|
免费无码婬片AAAA片直播香港|
国产乱妇无码一区二区三区黑寡妇
|
97伦理电影在线不卡|
日本阿v天堂在线观看|
99久久综合精品五月天 |
东京热无码中文字幕av专区|
A片太大太长太深好爽A片视频|
亚洲色偷偷一区二区手机在线|
美女诱惑亚洲一区|
午夜播放器在线观看|
亚洲第一成人无码A片|
在线看免费无码A片视频|
欧美精品狠狠色丁香婷婷|
成人做爰视频WWW网站|
2019日韩中文字幕MV|
国产成人黄色视频免费下载|
2019四虎影视最新在线|
欧美亚洲熟妇一区二区三区
|
亚洲中文字幕婷婷在线的|
麻豆爽爽妓女一区二区三区|
日日摸天天碰中文字幕|
一区二区国产盗摄精品|
影音先锋成人电影在线|
色婷婷激婷婷深爱五月小蛇|
国产精品亚洲第一区在线暖暖韩国
|
大乳秘书被CAO到哭H|
伊人草香蕉综在合线9|
久久久久久综合七次郎|
亚洲精品久久无码日韩绯色|
免费无码婬片AAAA片直播香港|
色狠狠一区二区三区熟女91|
亚洲卡二卡三无线乱码新区|
成人区精品一区二区婷婷|
一本大道香蕉视频大在线|
国产av一区二区三区 精品|
午夜激情免费影院|
熟婦人妻系列AV無碼一區二區|
又硬又粗进去爽A片免费无码|
亚洲精品久久久久中文字幕二区|
国内精品久久久久久网站|
熟岳大屁股疯狂迎合|
2014av天堂影音先锋|
久久99电影国产精品|
国产真实乱人偷精品人妻|
好紧我太爽了视频免费国产|
99久久久无码国产精品免费蜜柚|
日本黄H兄妹H动漫一区二区三区|
精品成人一区二区三区电影|
av在线一区二区中文字幕
|
国产精品欧美日韩人妻|
国产磁力链接在线播放|
97热久久精品中文字幕一区|
无套内谢大学生A片|
免费费很色视频大片|
五月丁香啪啪激情综合5109|
日本视频电影不卡无玛|
精品亚洲国产成人AV制服丝袜|
午夜亚洲乱码伦小说区69堂|
亚洲色欲色欲WWW在线丝|
精品国产偷窥一区二区久久|
丁香花五月天婷婷夜色|
av在线免费看网站|
无码AV免费一区二区三区A片|
国产亚洲精品成人AA片在线播|
激情A片久久久久久播放|
欧美熟妇另类久久久久久多毛|
国产xxxxxx久色视频在|
波多也结衣无码精品AV|
黄se网站是多少2013|
一起碰一起噜一起草视频|
欧美肉大捧一进一出免费视频|
无码人妻视频又大又粗欧美|
MATURETUBE乱妇|
色WWW永久免费视频首页|
国产亚洲福利在线视频|
成人午夜福利电影天堂|
欧洲无人区卡一卡二卡|
欧美日韩国产第1页|
国色天香一线二线三线|
美女露全乳视频短片|
久久99热人妻偷产国产|
丰满少妇伦精品无码专区|
99久久国产露脸精品麻豆|
国产精品一色一情一伦|
亚洲国产AV一区二区三区四区|
粉嫩merna人体丰满欣欣赏|
国产二级一片内射视频插放|
色婷婷亚洲婷婷五月|
香蕉人人超人人超碰超国产|
99在线观视频免费观看|
日日摸夜夜添夜夜添A片牛牛影视|
超精品手机国产在线|
免费含羞草AV片成人|
日韩人妻无码一区二区三区中文|
成人精品一区日本无码网站|
成人无码T髙潮喷水A片动漫小说|
久久免费看少妇高潮A片2012|
国产亚洲综合一区柠檬导航|
岳的大肥屁熟妇五十路99|
51久久成人国产精品麻豆|
日韩精品一区二区无码
|
中文字幕一区二区在线2021|
8x8国产人妻精品一区二区|
国产8X人视频免费观看|
国产白丝美腿娇喘高潮的视频|
被黑人肉体暴力强奷在线播放|
午夜DY888国产精品影院
|
亚洲精品无码一区二区多久
|
最近中文字幕高清在线|
18禁宅男深夜免费网站无码|
麻豆短视频app官方|
AV无码AV天天AV天天爽|
www.无码一级视频|
少妇挑战3个黑人惨叫4P国语|
精品久久久久久成人AV|
fc2人成视频在线观看|
成人嘿咻色情一区二区|
一本大道香蕉视频大在线|
成人片毛片A片免费观看欧美|
5av国产精品爽爽ⅴa在线观看|
久久免费看少妇高潮A片手机版|
好爽好深好猛好舒服视频上|
CAO死你好紧好爽好湿视频男男
|
国产呦交精品免费视频|
欧洲一卡2卡3卡4卡免费观看|
成人精品一区二区三区A片用毒蛇|
久久无码人妻中文国产AV|
成人嘿咻色情一区二区|
男妓跪趴把舌头伸进我的嘴巴
|
伊人久久大香线蕉AV一区二区|
男人和女人一级黄色大片|
亚洲精品无码av无码专区一本|
国产农村县城艳色歌舞团一区二区|
亚洲 第一区 欧美 日韩|
黑寡妇巨大粗爽毛片欧美|
亚洲人成电影网站在线观看|
边做边爱完整版免费视频播放视频|
FREE性丰满白嫩白嫩的HD|
97精品国自产在线偷拍|
少妇女BBxBBxBBxBBx|
波多野结衣紧身裙女教师|
香蕉国产精视频在线观看|
国产人妻午夜在线无码|
人妻无码一二三区|
日本一道综合久久?ⅴ免费|
国产成人精品a视频三区|
日韩精品一区二区无码|
1024免费看片|
亚洲高清国产拍精品5g|
欧美日韩中文在线播放专区|
午夜理论日本乱人伦片中文|
国产一级性爱视频|
真人做爰高潮全过程毛片|
亚洲AV综合AV国产AV|
亚洲精品久久久久中文另类
|
撕开奶罩揉吮奶头的A片|
亚洲 欧美 自拍 动漫 免费|
高潮无遮挡成人A片在线看|
亚洲免费视频久久|
99精品又大又爽又粗少妇毛片|
俄罗斯大胆少妇BBW|
日本一道人妻无码一区视频|
成人午夜伦理福利电影|
91久久夜色精品国产网站|
对白精彩的国产3p视频|
97人妻超在线观看免费|
蜜臀AV色欲A片无人一区|
在线观看黄色视频国产|
国内精久久久久久久久久人|
亚洲一卡2卡3卡4卡乱码网站|
永久AV狼友网站在线观看|
久久99热只有频精品6狠狠|
免费A片全黄少妇7777|
老女人熟女人妻国产|
国产激情久久99久久|
高H猛烈失禁潮喷G片在线观看|
中文字幕2018年最新中字版|
国产免费AV片在线播放唯爱网|
4HU影库最新永久地址入口|
AV天堂久久天堂色综合 |
色情WWW成人片WWW222|
91精品国产高清在线观看|
丰满性感少妇精品一二区|
99久久久无码国产精品免费蜜柚|
精品无人区卡一卡二卡三|
精品一区二区三区在线成人
|
欧美熟妇乱人伦A片免费高清|
91国模少妇一区二区三区|
99精产国品一二三产品香蕉|
永久精品一区二区三区亚洲|
国产a级作爱片无码|
国产一国产一本到免费|
俄罗斯娇小的学生VIDEOS16HD|
欧美做A视频一区|
摸BBB揉BBB添BBB|
久久夜色精品国产亚洲噜噜|
67pao成人国产永久免费|
日本xxxxxxx69xx|
免费视频网站一级人爱视频|
黄色一级电影久久|
国产成人精品a视频三区|
美女视频黄a视频全免费网站色窝|
艳妇臀荡乳欲伦交换AV1|
人妻被下春药中文字幕|
国精品无码人妻一区二区三区|
少妇成熟A片无码专区小说|
亚洲影院免费观看|
亚州一区二区三区成人片|
白丝jk网站国产免费|
yyy144永久免费观看|
国产女13黄A片AAA片视频|
婷婷开心色四房播播在线|
操人亚洲欧美精品 |
一道本日本视频无码|
乱码中字芒果视频一二三多人
|
中文无码妇乱子伦视频国产精品亚洲LV粉色
|
国产日韩精品视频一区二区三区|
吉根柚莉爱在线乱码亚洲|
300部大龄熟乱视频|
成人免费看A片WWW|
麻豆AV一区二区三区|
好看AV中文字幕在线观看|
欧美日韩中文在线播放专区|
男人大JI巴做爰好爽视频|
性一交一乱一美A片69XX|
亚洲AV无码A片一二三区|
99久久久无码国产AAA精品|
最新中文字幕乱码视频|
中国老熟妇自拍HD发布|
国产乱妇无码一区二区三区黑寡妇
|
国产后入清纯学生妹|
成人无码区免费A片视频韩国|
少妇伦子伦情品无吗|
国产狂喷水潮免费网站www|
中文字幕亚洲男人的天堂网络|
国产成人精品日本亚洲11|
japanese在线播放国产|
真实国产乱子伦对白在线播放
|
亚洲A片成人无码久久精品|
成人无码T髙潮喷水A片动漫小说|
亚洲午夜视频在线观看|
四虎影库884aa.www223|
成人免费A级毛片 |
亚洲欧美综合人成在线|
久久无人区卡三卡4卡|
特级毛片在线大全免费播放|
无套内射CHINESEHD熟女|
精品国产免费第一区二区|
成人国产欧美大片一区|
欧美精品狠狠色丁香婷婷|
婬荡的护士吴梦梦AV剧情|
亚洲另类欧美在线电影|
CHINESE大学生啪啪VIDEO
|
双飞两个丰满少妇11P|
久久久久久久久久久96av|
国产SUV精品201|
国产妓女一级在线|
两人性潮高免费视频看|
一本久到久久亚洲综合|
国产乱码卡二卡三卡老狼在线观看
|
麻豆一区二区三区蜜桃免费
|
四虎影视884A精品国产|
H狠狠躁死你H各种姿势|
男女做爰猛烈动高潮A片免费应用|
免费国产黄线在线播放|
黄片视频在线观看免费|
www.日本一区二区|
91午夜无码鲁丝片久婷99精品华液
|
大香伊蕉在人线国产手机看片|
yyy144永久免费观看|
成人毛片18美女免费|
男男啪啪激烈高潮喷出GIF|
最近日本MV字幕免费观看视频|
日本精品无码一区二区三区久久久|
2019日本一道国产|
99在线在线视频观看|
国产精品日本不卡一区二区|
5月丁香婷婷网俺来也|
老女老肥熟国产在线视频|
国产成人精品一区二区免费|
免费看美女禁处爆涌视频|
9视频国产1在线观看免费|
日韩一卡2卡三卡4卡分区乱码|
小雪被老外性调教1-8|
国产又粗又猛又黄又爽A片|
国产成人黄色视频免费下载|
日产乱码一区二区三区在线|
人妻AV中文字幕无码专区|
精品人妻无码一区二区三区牛牛|
日本乱理伦片在线观看胸大|
国产精华液女人十八毛片a|
一区二区亚洲精品国产精华液|
成人WWW色情在线观看|
又粗又大又黄的少妇毛片|
精品国产成人AV在线看|
男人J桶进女人下部无遮挡A片|
国产卡一卡二卡3卡四卡精品|
亚洲国产网综合在线|
又硬又粗进去爽A片免费无码安娜|
调教超级YIN荡玩物学生H|
少妇刮伦人妇A片1级|
麻豆乱码1区2区新区|
成人在无码AV在线观看一|
国产精品久久久久一区二区三区共
|
国产成人一区二区三区高清|
抖音WWW视频在线观看|
欧美激情无码一区二区三区明星|
日本卡一卡二卡三入口|
三男挺进一女爽爽爽小说|
亚洲国产欧美日本视频|
男人J桶进女人下部无遮挡A片|
91国产自产精品a|
成AV免费大片黄在线观看|
成人a级特黄毛片|
国产大尺度吃奶无遮无挡|
国产Av影片麻豆精品传媒|
韩国无码又爽又刺激的A片|
亚洲色综合中文字幕在线|
亚洲综合AV色婷婷五月蜜臀|
国产aⅴ精品动漫一区二区|
成年美女黄网站色大免费视频|
yyy144永久免费观看|
久久强奷乱码老熟女|
不充会员的爽爽影院|
精品人妻少妇一区偷拍视频|
欧美群交射精内射颜射潮喷|
欧美不卡1卡2卡三卡2022免费
|
欧美无人区码卡二卡3卡4|
免费观看a毛片一区二区不卡|
91人妻岛国视频免费看|
欧美高清在线视频一区二区|
日韩一二区色情高清清视频|
欧美牲交A欧美牲交|
寡妇大J8又粗又大|
久碰久摸久看视频在线观看
|
一本久到久久亚洲综合|
91亚洲精品五月天|
乱码午夜-极品国产内射|
激情五月综合色婷婷一区二区
|
92看片淫黄大片一级|
免费区大尺码体验区|
欧美大尺度无遮挡A片杏仁|
chinese中国人自拍在线|
国产精品亚洲精品久久品|
91肉色超薄丝袜脚交一区二区|
亚洲AV无码乱码国产麻豆穿越
|
亚洲欧美日韩国产|
中文字幕人妻熟女人妻|
日韩色情免费高速视频|
欧美日本亚洲一区二区在线观看|
丰满放荡岳乱蜜桃AV|
野花日本中文字幕MV|
99C视频色欲在线|
国产一区二区三区国产精品
|
日韩欧美群交p片内射中文|
国产麻花豆剧传媒精品MV在线|
国产小视频免费在线观看|
91精国产品一区二区|
黄色视屏在线免费播放
|
123国产日韩在线视频|
亚洲无码乱码在线观看|
人妻AV中文字幕无码专区|
亚洲AV成人影视在线观看|
卡一卡二卡三免费视频|
午夜伦yy44880影院|
丝袜精品国产香蕉在线|
18csgo.cn|
欧美精品久久99人妻无码|
131美女视频爱做国产|
国产乱子伦精品无码码专区
|
久久国产人妻一区二区免色戒电影|
欧美日韩国产精选福利片|
91正在播放极品白嫩在线观看|
91精品国产91 |
人妻换人妻AA视频|
蜜臀av性久久久久蜜臀aⅴ流畅|
成人做爰免费A片视频二机片|
一个人视频在线观看www中文|
欧美阿v高清资源在线|
点击进入av毛片在线|
国产精品色情AAAAA片软件|
午夜福利1000集无码|
国内精品国产成人国产三级|
97人妻超在线观看免费|
岳m让我cao了一夜|
HEYZO无码综合国产精品|
亚洲一区精品99|
国产亚洲精品成人AA片在线播
|
日韩人妻AV一区夜夜|
亚洲AV无码专区A片奶水|
欧美mv日韩mv国产网站app|
国产一区二区无码精品小说|
国内卡一卡二卡三免费网站|
欧美人与动牲交ZOOZ男人
|
99热久久这里只有精品|
国产97精品无码A片在线看密|
老师的粉嫩小又紧水又多A片视频|
日本亚洲精品无码区国产电影|
亚洲一区二区观看播放|
国产精华一区久久久久|
www.射.com|
影音先锋av资源看波波|
日韩美女乱淫试看屁视频网站|
伊人久久大香线蕉AV一区二区|
国产xxxxxx久色视频在|
97碰碰人妻无码视频免费|
亚洲AV小说最新在线网址|
日本一区二区丝袜|
精品亚洲国产成AV人片传媒|
日韩精品免费一区二区|
好爽好深好猛好舒服视频上|
国产免费无码又爽又刺激A片|
老牛无码人妻精品1国产|
成人性生交A片免费看|
明星性猛交ⅩXXX乱大交|
久久一级免费全裸视频|
久久人妻精品白浆国产|
偷窥wc美女毛茸茸视频|
丰满性感少妇精品一二区|
久久久国产人妻精品|
亚洲视频在线观看网站|
8x8国产人妻精品一区二区|
久久精品免费人成人A片|
又硬又粗进去好爽A片春色视频|
(凹凸)最新毛片婷婷99精品视频|
亚洲aⅤ无码专区国产乱码不卡|
十八岁末年禁止免费观看|
天天影视欲香欲色成人网|
午夜福利杨幂在线视频
|
免费v片所有免费网站|
国产呦交精品免费视频|
青青草国产97免费观看|
久久yy99re66|
日日碰狠狠躁久久躁96AVV|
久久国产精品免费观看|
猫咪av最新永久网址无码|
国产嫖妓一区二区三区无码|
久久草免费线看线看2|
成人WWW色情在线观看|
美女羞羞喷液视频免费|
亚洲 欧美 自拍 动漫 免费
|
一道本在线伊人蕉无码|
日韩18视频在线观看|
边摸边吃奶做爽A片视频|
国内精品偷拍在线观看|
青草青草久热精品视频在线百度云|
国产又色又粗又黄又爽免费|
国产又黄又爽又色的免费|
国产在线拍国产拍拍偷|
WWW射我里面在线观看|
欧美一级黄色日韩|
性生生活色欲片性按摩|
精品国产污网站直接看|
粉嫩av一区二区白浆|
免费视频网站一级人爱视频
|
成人午夜AV亚洲精品无码网站|
99久久久久久亚洲精品|
北条麻妃视频在线|
四虎8848a成人亚洲五品|
国产午夜亚洲精品理论片八戒|
亚洲日韩精品AV中文字幕|
丰满少妇高潮惨叫在线观看|
国产av巨作情欲放纵无码下载|
免费国产黄网站在线看品善网|
很黄很黄地在床视频女|
丰满少妇理伦A片在线看|
久久99精品国语久久久|
亚洲午夜视频在线观看|
全黄做爰100分钟视频|
91精品国产观看免费观看|
国产高清视频在线观看97|
午夜伦伦电影理论片大片|
欧美日韩中文字幕一区二区高清|
2023国产无人区卡一卡二卡三|
亚洲国产一卡2卡3卡4卡5公司|
国产人妖在线另类专区|
最新激情中文字幕视频|
龙欲h粗喘强占公妇H|
亚洲欧洲成人精品AV97|
久久人妻精品白浆国产|
精品亚洲国产成AV人片传媒|
朋友人妻翘臀迎接我粗大撞击|
国产偷V国产偷V亚洲高清学生|
无套内谢少妇毛片A片打工皇帝|
www亚洲综合色图视频com|
日本一区二区丝袜|
男人猛躁进女人毛片A片|
成人免费一区二区三区|
精品人妻一区二区三区日产|
午夜亚洲福利在线老司机|
亚洲?V中文字幕无码久久|
日本吻胸视频成人A片无码
|
在线视频免费观看爽爽爽|
AV免费一区二区三区|
欧美特级特黄AAAAA片|
中文字幕无线码中文字幕|
四虎亚洲精品高清在线观看
|
蜜桃臀无码AV在线观看|
成人在无码AV在线观看一|
亚洲精品久久久久久一区|
黄片长版看嘛 直播片|
FREE性丰满白嫩白嫩的HD|
37西西人体做爰大胆视频|
漂亮的保姆5韩国电影中字|
222com奇米第四色|
777色情在线无码|
精品无人区卡卡二卡三乱码|
国产一区二区三区在线观看精品
|
国自产拍偷拍精品啪啪模特李宗瑞|
女同志videos最新另|
精品久久久久久久久久久久|
久久这里只有精品1|
92久久精品一区二区|
人人操人人操人人操|
色情毛片AAAAAA片毛片|
HEYZO无码综合国产精品|
免费番肉动漫在线观看|
亚洲日韩大佬色蜜桃91|
2019久久视频在线视频|
99er久久国产精品在线|
丰满放荡岳乱蜜桃AV|
国产精品_卡2卡三卡4卡|
99久久国产综合精麻豆|
中文日产幕无线码一区2021|
真实国产精品视频国产网|
亚洲精品深夜AV无码一区二区|
午夜精品成人一区二区视频|
国产SUV精品一区二妻|
日韩一卡2卡三卡4卡无卡网站|
91免费永久国产在线观看|
草莓视频在线观看网址 |
少妇A片出轨人妻偷人视频|
国产精品一区二区熟女不卡|
波多野结衣+蜜臀|
天堂VA蜜桃一区二区三区|
色情内射少妇兽交|
久久女人被添全过程A片|
日韩欧美中文字幕在线点播|
日本一本二本无码免费视频|
99久久久无码国产精品免费蜜柚|
影视AV久久久噜噜噜噜噜三级|
国产亚洲va在线电影|
国产成人91一区二区三区APP|
啊轻点灬大JI巴又大又粗|
亚洲欧视在线观看|
男女肉粗暴进来动态图|
思思久久99热只有频精品66|
国产又粗又猛又爽黄老大爷视频|
最新国产色视频在线播放|
嫩BBB搡BBBB榛BBBB|
免费又色又爽1000禁片|
天天综合网在线观看视频|
91欧美日韩在线一区|
久久久久亚洲AV手机播放|
久久免费看少妇高潮A片麻豆|
国产乱妇无码一区二区三区黑寡妇|
嗯灬啊灬把腿张开灬A片MBA|
国产亚洲精品A片久久久|
嫩草影院一二三区入口首页|
欧美精品3atv一区二区三区
|
嫩模写真一区二区三区三州|
捏胸亲嘴床震娇喘视频在线播放|
无码无遮挡成人A片|
亚洲精品一区二区三区无码A片|
成人麻豆日韩在无码视频|
国产开女娃苞A片在线播放|
男女做爰猛烈吃奶摸A片|
91亚洲最新精品|
麻豆精东九一传媒在线观看|
欧美无人区码卡二卡3卡4|
首页图区国产亚洲欧美|
国产成人va在线播放免费|
国产一区二区四区在线观看|
女人囗交吞精口视频|
九九九免费观看视频|
国产亚洲精品久久精品69|
免费精品国产人妻国语麻豆|
波多野结衣+蜜臀|
精品欧美乱码久久久久久1区2区|
狠狠躁日日躁夜夜躁A片55动漫|
国产国语 毛片高清视频|
男人猛躁进女人毛片A片|
少妇A片出轨人妻偷人视频|
99爱第一视频在线观看|
高清国产摸出水在线视频|
国产欧美精品AAAAAA片|
未满十八禁止看床片视频|
日本阿v手机不卡在线观看视频
|
国产男女做爰猛烈叫床小说|
日本亚州欧州国产中文天堂|
免费无码又爽又黄又刺激网站|
草草视频网站在线观看|
国产成人精品一区二三区在线观看|
日本吻胸视频成人A片无码|
久久大香伊蕉在人线免费|
精品久久久久久成人AV|
亚洲中文字幕无码一久久区|
亚洲gv天堂gv无码男同|
强奸日本大奶子片一区二区|
无码又爽又刺激A片涩涩动漫软件|
996这里只有精品|
WBBBB搡BBBB搡BBBB|
亚洲乱码日产一区三区|
中文字幕亚洲欧美日韩2019|
亚洲欧美人成无码苍井空|
国产精品无码久久久最先观看|
免费无码婬片AAAA片直播香港|
色老头永久免费视频|
免费观看a毛片一区二区不卡|
日韩人妻无码一区二区三区中文|
鲁鲁狠狠狠7777一区二区|
四川寡妇高潮AAA片毛片|
高潮精品一区二区|
人妻日本无中文字幕无码|
亚洲AV综合AV国产AV|
成人黄网站A片免费观看|
我和丰满老师疯狂做爰在线观看|
国产精品一区在线观看你懂的|
女人18毛毛片兔费码A片|
日韩精品专区在线影院重磅|
免费无码一线A片AAA片|
一级A婬片试看28分钟
|
亚洲精品久久无码AV片俺去也|
日韩中文字幕色网视频
|
99久久久无码国产AAA精品|
www.av天堂.com|
亚洲欧美一区二区久久|
伊人大蕉久75影院在线播放
|
熟妇的荡欲色综合亚洲图片|
东北女人无套内谢视频|
免费鲁丝无码下属一级|
色天天爱天天狠天天透|
欧洲精品不卡1卡2卡三卡四卡|
色情爱视频网站免费观看|